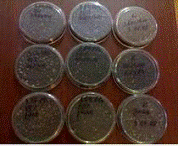
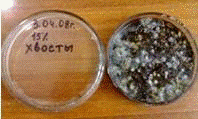
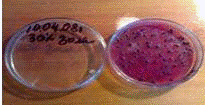
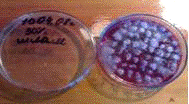
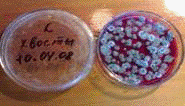

Утилизация промышленных отходов с использованием вермикомпоста (продукта жизнедеятельности красных калифорнийских червей)
Федеральное агентство по образованию
Кузбасская государственная
педагогическая академия
Естественно-географический факультет
Кафедра ботаники
Выпускная квалификационная работа
по биологии
Утилизация промышленных отходов с
использованием вермикомпоста (продукта жизнедеятельности красных калифорнийских
червей)
студента 5 курса 4 гр. очной формы обучения
Ибрагимова Садига Советовича
Научный руководитель:
доктор сельскохозяйственных наук,
зав. кафедрой А.С. Водолеев
Новокузнецк 2012
Содержание
Введение
Глава 1. Объекты и методы исследования
.1 История изучения дождевых червей
.1.1 Биология дождевых червей
.1.2 Основные представители люмбрицид
.1.3 Экология дождевых червей
.1.4 Роль дождевых червей в процессах почвообразования
.1.5 Калифорнийский красный червь и владимирский «старатель»
.1.6 Качественная и количественная характеристика биогумуса
.2 Сорт яровой пшеницы «Новосибирская-29»
.3 Характеристика промышленных отходов
.3.1 Отходы железорудного обогащения Абагурской аглофабрики
.3.2 Золошлаковые отходы Томь-Усинской ГРЭС
.3.3 Шламовые отходы ЗСМК
.4 Методика проводимых исследований
.4.1 Условия проведения лабораторного эксперимента
.4.2 Определение содержания хлорофилла в проростках злака
.4.3 Цитохимический анализ на содержание тяжёлых металлов
.4.4 Определение видового состава почвенных микроорганизмов
Глава 2. Результаты исследования и обсуждение результатов
.1 Результаты исследований 3-го дня лабораторного
эксперимента
.2 Результаты исследований 7-го дня лабораторного
эксперимента
.3 Результаты опыта по определению содержания хлорофилла в
проростках злаков
.4 Результаты цитохимического анализа на содержание тяжёлых
металлов
.5 Результаты опыта по определению видового состава почвенных
микроорганизмов
Глава 3. Практическое использование материалов работы
.1 Содержание дождевых червей в домашних условиях
.2 Культивирование дождевых червей на садовом участке
.3 Урок биологии по теме «Тип Кольчатые черви. Класс
Малощетинковые черви. Внешнее и внутреннее строение малощетинковых на примере
дождевого червя. Значение дождевых червей в природе и в жизни человека»
Заключение
Список использованной литературы
Введение
Актуальность. В настоящее время существует проблема деградации почв,
снижения её плодородия, остро стоит проблема утилизации органических отходов
городского и сельского хозяйства, отходов промышленного производства. Причиной
возникших проблем является неразумная хозяйственная деятельность человека:
неумеренное употребление удобрений и пестицидов, вырубка деревьев и
кустарников, перевыпас скота, несовершенство технологий безотходного
производства в промышленности, следствием которого является накопление в
отвалах, полигонах десятков миллионов тонн отходов и загрязнение почв тяжёлыми
металлами. Из них полтора миллиарда тонн - токсичные (обладают
общетоксическими, токсико-генетическими, эмбриотоксическими, канцерогенными и
другими негативными свойствами). Четыре тысячи промышленных отвалов
переполнены. Многие из них находятся в аварийном состоянии.
Существующие проблемы заставляют изыскать возможности применения
экологически чистых и безотходных технологий для повышения плодородия почв и
утилизации отходов городского и сельского хозяйства, промышленного
производства. Одним из перспективных направлений является - утилизация
промышленных отходов биологическим способом (с использованием вермикомпоста,
или биогумуса) и создание на их поверхностях устойчивых культурфитоценозов.
В результате селекции красных дождевых червей человеком были получены
гибриды, которые используются для переработки и утилизации органических отходов
с целью получения ценного продукта - биогумуса. В природе дождевые черви являются
биологическим фактором процесса почвообразования. Они разрыхляют почву на
большую глубину, содействуя проникновению воздуха и влаги, перепахивают почву,
способствуют накоплению в почве органических веществ и образованию перегноя.
Объекты исследования - отходы железорудного обогащения хвосто-хранилища
Абагурской аглофабрики, шламовые отходы ЗСМК и золошлаковые отходы
Томь-Усинской ГРЭС; вермикомпост - продукт переработки красных калифорнийских
червей; яровая пшеница сорта «Новосибирская-29».
Предмет исследования - восстановление плодородия техногенно нарушенных земель с
использованием органических мелиорантов - продукта переработки красных
калифорнийских червей.
Целью данной работы является изучение возможностей дождевых червей в процессе
почвообразования, практического применения продукта их жизнедеятельности -
вермикомпоста в процессе утилизации промышленных отходов угольной,
металлургической и энергетической отраслей для создания устойчивого травостоя и
оздоровления окружающей природной среды.
Исходя из цели работы, были поставлены задачи:
. Изучить общие вопросы биологии, жизнедеятельности дождевых червей,
обобщить зарубежный и отечественный опыт по вермикультивированию.
. Разработать практические рекомендации по содержанию дождевых червей в
домашних условиях, культивированию их на садовом участке и получению
вермикомпоста.
. В практическом исследовании показать возможность применения
вермикомпоста для утилизации производственных отходов.
. На основе материалов работы разработать урок по биологии по теме «Тип
Кольчатые черви».
Методы исследования: полевой (сбор материала), описательный, лабораторный
эксперимент, микроскопический, метод количественной оценки содержания пигментов
(оптический с использованием фотоэлектроколо-риметра), цитохимический,
морфологический.
Апробация. Материалы настоящей работы были изложены в докладе
«Утилизация промышленных отходов с использованием вермикомпоста» на второй Международной
научно-практической конференции «Управление отходами - основа восстановления
экологического равновесия в Кузбассе» (Новокузнецк, 2008 г.) [20], на
межвузовской студенческой конференции при филиале Санкт-Петербургского
института внешнеэкономических связей, экономики и права (Новокузнецк, 2009 г.).
Практическая значимость. Результаты исследования могут быть использованы при
проведении рекультивационных мероприятий специалистами-мелиораторами,
садоводами-любителями при подготовке почвы к посадке рассады, цветоводами при
формировании почвосмесей для комнатных растений, а также на уроках биологии в
7-ом классе в теме «Тип Кольчатые черви».
Структура и объём работы. Настоящая работа объёмом 93 страницы состоит из
введения, 3 глав, заключения, списка литературы, который содержит 32 источника
на русском языке. Работа иллюстрирована 46 рисунками, содержит 9 таблиц.
Выражаю особую благодарность своему научному руководителю за помощь в
написании настоящей работы: доктору сельскохозяйственных наук, заведующему кафедрой
ботаники Водолееву Анатолию Сергеевичу. Также благодарю библиотекарей Научной
библиотеки ЕГФ КузГПА за предоставленные книги.
Глава 1. Общие сведения о
культивируемых дождевых червях
.1 История
исследования дождевых червей
О пользе дождевых червей для плодородия земли было известно людям
издавна. Древние египтяне обожествляли дождевого червя, считая его священным
животным. Античные земледельцы знали, что на почвах, где водятся черви, урожай
всегда богаче.
Первые системные научные исследования дождевых червей, проводившиеся
рядом учёных в Англии, Франции и Германии относятся к первой половине XIX века. Однако основной вклад в
развитие этой темы внёс Чарльз Дарвин, который заинтересовался дождевыми
червями ещё в молодые годы и посвятил их изучению более 40 лет жизни. В своей
классической работе «Образование растительного слоя земли деятельностью
дождевых червей и наблюдения над их образом жизни», опубликованной им за год до
смерти в 1881 году он отмечал, что «...Почва правильно обрабатывалась червями и
будет обрабатываться ими... Черви превосходным образом подготавливают землю для
роста растений... Весь существующий растительный слой уже не раз прошёл через
кишечный канал червей и ещё пройдёт много раз... Тщательно перемешивают они всю
почву, подобно садовнику, готовящему измельчённую землю для своих самых
изысканных растений... Весьма сомнительно, чтобы нашлись ещё другие животные,
которые в истории земной коры заняли бы столь видное место» [18].
В России первыми исследованиями почвообразовательной деятельности
дождевых червей в конце XIX
века, продолжив работу Ч. Дарвина, занимался Г.Н. Высоцкий. Полученные им
результаты, а также труды таких учёных, как Н.А. Димо и М.С. Гилярова расширили
и углубили сведения о дождевых червях и их роли в почвообразовании [15, 16,
17]. Однако, затем на долгие годы дождевой червь, как объект изучения, был
забыт и более полувека ни биологи, ни почвоведы не обращались к этой теме.
1.1.1
Биология дождевых червей
Дождевые черви относятся к типу Кольчатые черви (Phylum Annelidae), подтипу Поясковых (Subphyllum Clitellata), классу Малощетинковых червей (Classis Oligochaeta), отряду Люмбрикоморфы, или
Высших Малощетинковых, (Ordo Lumbricomorpha), семейству Настоящие
дождевые черви (Familia Lumbricidae), которое включает более 200 видов червей.
На территории России обитает около 100 видов дождевых червей, среди
которых лишь немногие поддаются разведению. Наиболее привлекательными для
вермикультивирования являются черви, относящиеся к виду красных червей (Lumbricus rubellus). В результате их селекции был
получен «Гибрид красный калифорнийский», универсальный по своим характеристикам
и наиболее экономически эффективный. Он сохранил физиологические и
морфологические особенности, характерные для других дождевых червей, но в
отличие от своих «диких» сородичей имеет значительно большую продолжительность
жизни, более плодовит, очень вынослив, приучен жить в неволе. Утрата инстинкта
покидать место обитания делает возможным его разведение под открытым небом без
риска потери популяции.
Особенности внешнего строения. Тело червя сильно вытянуто в
поперечном сечении. Передний конец тела начинается небольшой подвижной головной
лопастью (простомиумом), лишённой глаз, антенн и пальп (рис. 1). За
простомиумом находится первый сегмент, или перистомиум, на котором с нижней
стороны расположен рот. Каждый сегмент, кроме перистомиума, снабжён четырьмя
парами пучков маленьких щетинок, торчащих непосредственно из стенки тела.
Щетинки направлены остриями назад и препятствуют движению тела червя при его передвижении
в земляных норках. С 32-го по 37-й членик имеется утолщение покровов,
охватывающее несколько сегментов, - поясок, или клителлюм, заключающий много
железистых клеток, секрет которых идёт на образование кокона. Тело червя
заканчивается небольшой анальной лопастью (пигидиумом) с анальным отверстием.

Рис. 1. Внешний вид дождевого червя
Кожно-мускульный мешок. Тело дождевого червя покрыто слоем кожного эпителия с
большим количеством железистых клеток. Кожа выделяет тонкую кутикулу. Обильное
выделение слизи защищает кожу дождевых червей от механических повреждений и
высыхания. Под кожей залегают кольцевые и продольные мышцы, изнутри выстланные
целомическим эпителием (рис. 2).

Рис. 2. Поперечный разрез из средней части тела дождевого червя
Полость тела. У дождевых червей имеется типичный сегментированный целом,
заполненный полостной жидкостью, с расположенными в нём внутренними органами. У
дождевых червей спинная брыжейка исчезает, а брюшная не доходит до брюшной
стенки тела. Она связывает кишечник с брюшным кровеносным сосудом и брюшной
нервной цепочкой. Целомическая жидкость может свободно поступать из одного
сегмента в другой. Целом осуществляет питательную, экскреторную и дыхательную
функции. Кроме того, целом выполняет опорно-двигательную функцию благодаря
несжимаемости целомической жидкости и перистальтическим движениям мускулатуры.
Пищеварительная система дождевых червей состоит из ряда хорошо
дифференцированных отделов - глотки, пищевода, зоба и мускульного желудка,
средней и задней кишки (рис. 3). В пищевод впадают три пары особых известковых
желёз, секреты которых нейтрализует гуминовые кислоты в пище дождевых червей.
Из пищевода пища поступает в зоб, где накапливается, а затем небольшими
порциями переходит в мускульный желудок. Здесь происходит измельчение
растительных остатков путём перетирания их между минеральными частицами грунта.
Из желудка пища поступает в среднюю кишку, где происходит всасывание
питательных веществ. Средняя кишка образует на спинной стороне складчатый
выступ - тифлозоль, вдающийся внутрь просвета кишки и увеличивающий всасывающую
поверхность кишки. Непереваренные остатки пищи и минеральные частицы почвы
поступают в короткую заднюю кишку и удаляются через анальное отверстие.

Рис. 3. Пищеварительная система дождевого червя
Дыхательная система. Основным и единственным органом дыхания служит кожа, в
которой разветвляется густая сеть капилляров. После дождя вода проходит через
верхние слои почвы, где поглощается имеющийся в ней кислород. Такая вода,
лишённая кислорода, губительна для дождевых червей. Когда вода заливает норки,
черви, спасаясь от неё, вынуждены выползать на поверхность (отсюда - название
«дождевые черви»).
Кровеносная система. У дождевых червей имеется хорошо развитая замкнутая
кровеносная система. Имеются спинной и брюшной пульсирующие сосуды, которые
связаны кольцевыми сосудами. Кольцевые сосуды переднего конца тела,
охватывающие пищевод, самостоятельно пульсируют, за что их называют сердцами
(рис. 4). Циркуляции крови также способствуют перистальтические движения тела
червя. Плазма крови обычно содержит вещество, близкое к гемоглобину, которое
придаёт крови красный цвет.

Рис. 4. Анатомия дождевого червя
Выделительная система. Органы выделения представлены типичными метанефридиями,
имеющими сложное строение. Свойство метанефридиев к экономии влаги в организме
путём реабсорбции воды обеспечивает приспособленность дождевых червей к жизни в
почве. Твёрдые экскреты накапливаются в хлорагенных клетках целомического
эпителия. Частично эти клетки, наполненные экскретами, удаляются через воронки
нефридиев или через особые поры в стенке тела.
Нервная система. У дождевых червей имеются типичные для кольчецов
парные надглоточные ганглии и брюшная нервная цепочка
Органы чувств у дождевых червей развиты слабо, что объясняется их
жизнью в почве. В коже много чувствующих клеток: светочувствительных,
осязательных и др. (рис. 5). Дождевые черви чутко реагируют на свет, влажность
и температуру. Этим объясняются их вертикальные миграции в почве в течение
суток и по сезонам.

Рис. 5. Поперечный разрез через участок кожно-мускульного мешка и
чувствительную почку дождевого червя
Половая система, размножение и развитие. Дождевые черви - гермафродиты. В
10-м и 11-м сегментах тела залегают 2 пары семенников, лежащих в семенных
капсулах, семенники прикрыты тремя парами особых семенных мешков, последние
развиваются как выпячивания диссепиментов (рис. 6). В семенные мешки половые
клетки попадают из семенных капсул, после того как они отделились от
семенников. В семенных мешках половые клетки окончательно созревают, и зрелые
спермии поступают обратно в семенные капсулы. Для их вывода служат специальные
протоки. Против каждого семенника имеется по мерцательной воронке, от которой
назад отходит выводной канал. Оба канала каждой стороны сливаются в один
продольный семяпровод, открывающийся на брюшной стороне 15-го сегмента. Половые
воронки вместе с выводными протоками представляют настоящие целомодукты, то
есть образования мезодермальной природы.
Женская половая система образована одной парой очень мелких яичников в
13-м сегменте и парой коротких, ворончатых яйцеводов, открывающихся на 14-м
сегменте. Задний диссепимент женского сегмента образует яйцевые мешки, сходные
с семенными мешками (см. рис. 6). Кроме того, к женской системе относятся ещё 2
пары глубоких кожных впячиваний, семяприёмников на брюшной стороне 9-го и 10-го
сегментов. Эти мешочки, не имеющие никакого сообщения с полостью тела, служат в
качестве семяприёмников при перекрёстном оплодотворении.
Косвенное отношение к половой системе имеют ещё многочисленные
одноклеточные желёзки, образующие на поверхности тела на протяжении 32-37-го
сегментов кольцевидное утолщение - поясок, или клителлюм. Они выделяют слизь,
служащую для образования яйцевого кокона, и белковую жидкость, идущую на
питание развивающегося зародыша.
Оплодотворение дождевых червей перекрёстное. Два червя прикладываются
брюшными сторонами, головы обращены друг другу навстречу. Поясками обоих червей
выделяется слизь, одевающая их в виде двух муфт, поясок одного червя
располагается против отверстий семяприёмников другого. Из мужских отверстий обоих
червей выделяется сперма, которая сокращением брюшной мускулатуры проводится по
его поверхности к пояску, где и попадает в упомянутую ранее слизистую муфту.
Семяприёмники партнёра производят при этом как бы глотательные движения и
воспринимают поступающее в муфту семя. Таким образом, семяприёмники обоих
особей заполняются чужим семенем. Так происходит копуляция, после чего черви
расходятся. Откладка яиц и их оплодотворение происходит значительно позже.
Червь выделяет вокруг своего тела, в области пояска, слизистую муфту, в которую
и откладываются яйца. Затем муфта сползает с червя через его головной конец. Во
время прохождения муфты мимо 9-го и 10-го сегментов семяприёмники вдавливают в
муфту находящееся в них чужое семя, которым яйца и оплодотворяются. Муфта после
этого смыкается на концах, уплотняется и превращается в яйцевой кокон, под
защитой которого и происходит развитие яиц. Яйца развиваются внутри яйцевого
кокона, из которого выходит уже вполне сформированный червь. Кокон содержит
питательную белковую жидкость, а яйца бедны желтком и, развиваясь, дают
зародыш, который активно заглатывает белок [19, 22, 23, 31].

Рис. 6. Саггитальный разрез половых сегментов дождевого червя
1.1.2
Основные представители люмбрицид
Центральным семейством отряда Lumbricomorpha является семейство люмбрицид, или
настоящих дождевых червей (Familia Lumbricidae), включающее до 200 видов. Зоологи различают виды дождевых
червей по особенностям строения органов размножения, по расположению щетинок и
другим особенностям [25].
Один из наиболее обычных в средней полосе европейской части России видов
дождевых червей - Lumbricus terrestris (рис. 7) - отличается крупными размерами (длина до 30 см, толщина до 1
см), имеет уплощённый и расширенный хвостовой конец и тёмно-красную с
фиолетовым оттенком окраску спинной стороны в передней трети тела, остальная
часть лишена пигментации и имеет грязно-розовый цвет. Только вдоль середины
спины тянется узкая тёмно-красная полоса. Его также называют большой красный
выползок. Щетинки у него расположены на сегментах четырьмя парами, а поясок
простирается с 32-го по 37-й сегмент. В земле роет глубокие ходы, уходящие от
поверхности на 2 м и больше. В тёплую и сырую погоду по ночам эти черви
вылезают из норок, но не совсем, а, цепляясь хвостом за отверстие, так что в
случае опасности могут быстро скрыться. Вытягиваясь, они обшаривают окружающее
пространство, захватывают ртом опавшие листья, полусгнившие травинки и другую
растительность, затаскивая их в свои норки. Черви заглатывают и землю.
Органические вещества почвы, перегной используются в качестве пищи, песчинки
способствуют измельчению и перетиранию проглоченных кусочков листьев. Когда
червь зарывается в землю с поверхности или когда роет новый ход в толще почвы, он
действует передним концом как клином, попеременно то сужая и втягивая его, то,
вздувая и сокращая, таким образом расталкивая частицы почвы в стороны. Большую
роль при этом играют щетинки, цепляющиеся за стенки хода и не дающие
возможности телу червя соскальзывать назад при его сокращении. По поверхности
земли, не имея опоры со всех сторон, черви передвигаются сравнительно медленно,
а внутри своих ходов довольно быстро.

Рис. 7. Обыкновенный дождевой червь, большой красный выползок (Lumbricus terrestris)
К роду люмбрикус (Genus Lumbricus) принадлежат десять видов. Самый обычный на территории нашей страны -
малый красный червь, или малый выползок (Lumbricus rubellus). Он вдвое короче и тоньше большого
красного выползка, но окрашен ярче, вишнёво-красного цвета (рис. 8). Задний
конец его тела тоже уплощён и расширен, а поясок у него обычно расположен с
27-го по 32-й сегмент. Глубоких ходов, как большой выползок, не делает, обычно
держится в самом поверхностном слое почвы или в лесной подстилке среди гниющих
листьев.

Рис. 8. Малый красный выползок (Lumbricus rubellus)
Самый распространённый и часто встречающийся в средней полосе России -
вид Nicodrilus caliginosus (рис. 9), называемый иногда пашенным
червем, так как на пашнях и полях попадается чаще других; найти его можно также
и в лесах, на огородах и побережьях водоёмов. Это средних размеров (длиной до
15-16 см) сероватый червь, лишённый пурпурной пигментации, с пояском,
расположенным обычно на сегментах с 27-го по 34-й. Задний конец тела не
уплощён. Как и у других видов этого рода, щетинки на каждом сегменте сближены
попарно. В отличие от выползков, он держится обычно в толще почвы на глубине
5-16 см, где и питается главным образом почвенным перегноем. На поверхность его
могут выгнать только сильные дожди. Во время летней засухи уходит на глубину
40-60 см, свёртывается там клубком, иногда буквально завязываясь узлом,
выделяет слизь и с её помощью строит вокруг себя из почвенных частиц довольно
прочную защитную капсулу, впадая затем в неактивное состояние. Такая диапауза
может продолжаться больше 2 месяцев. Благодаря этой особенности Nicodrilus caliginosus более устойчив к засухе и может
заселять сухие, открытые места [16].

Рис. 9. Пашенный червь (Nicodrilus caliginosus)
Один из наиболее ярко окрашенных червей - навозный (Eisenia foetida), обладающий специфическим
неприятным запахом. Это сравнительно небольшой червь, длиной 6-10 см, с попарно
сближенными щетинками (рис. 10). Цвет его тёмно-красный или красно-коричневый,
но окраска не сплошная, а кольчатая, так как бороздки, разделяющие сегменты,
светлые, что особенно хорошо видно, когда червь сильно растянется. Навозный
червь очень широко распространён: на севере и в средней полосе он встречается
недалеко от жилья человека, в скоплениях навоза, гнилой соломы, в парниках. Но
в лесостепной полосе становится довольно обычным и в лесах, далёких от жилья,
где его можно найти в старых трухлявых пнях, дуплах, скоплениях прелых листьев
и по берегам речек и ручьёв. При раздражении навозный червь выделяет довольно
сильно пахнущую жёлтую жидкость.

Рис. 10. Навозный червь (Eisenia foetida)
К этому же роду относится и эйзения Норденшельда (Eisenia nordenskioldi), названная так в честь известного
шведского путешественника, исследователя полярных стран Норденшельда,
собравшего большие зоологические колеккции на севере Сибири. Этот вид
распространён по всей Сибири и на Дальнем Востоке, а также в восточной части
европейской территории России. По окраске и размерам он очень изменчив; типична
для него окраска, похожая на таковую у Lumbricus rubellus: довольно тёмная, вишнёво-красная,
причём задний конец несколько светлее. Характерны два светлых пятна по бокам
(на 9-11-м сегментах). Встречаются иногда и очень слабо окрашенные, почти
совсем светлые черви. В Сибири эйзения Норденшельда достигает длины 25-30 см; в
европейской части России он обычно мельче, всего 6-12 см. Интересно, что этот
вид многочислен и в тундре, в районе вечной мерзлоты; не так давно он был
найден даже на Ляховских островах, на вечных льдах.
Один из самых
мелких видов (длина тела 2,5-6 см) семейства люмбрицид - эйзениелла
четырёхгранная (Eiseniella tetraedra). Окраска его серовато-коричневая, с
желтоватым оттенком; поясок с 22-23-го по 26-27-й сегмент; задний конец тела
четырёхгранный. Это вид-амфибия, обитающий по берегам водоёмов, иногда его
можно найти и в воде у берега (рис. 11).

Рис. 11.
Эйзениелла четырёхгранная (Eiseniella tetraedra)
Итак,
рассмотрев основных представителей люмбрицид, сведём все данные в сравнительную
таблицу 1.
Таблица 1 -
Сравнительная характеристика люмбрицид
|
Вид дождевого червя
|
Окраска
|
Длина тела, см
|
Расположение пояска,
сегмент
|
Где обитает, характер
ходов, глубина проникновения
|
|
Большой красный выползок
|
тёмно-красная с фиолетовым
оттенком
|
до 30
|
с 32-го по 37-й
|
глубокие ходы, глубина
проникновения до 2 м
|
|
Малый красный выползок
|
вишнёво-красная
|
до 15
|
с 27-го по 32-й
|
поверхностный слой почвы,
ходы неглубокие
|
|
Пашенный червь
|
сероватая
|
до 15-16
|
с 27-го по 34-й
|
держится в толще почвы на
глубине 5-16 см
|
|
Навозный червь
|
тёмно-красная или
красновато-коричневая
|
до 6-10
|
с 22-го по 27-й
|
в скоплениях навоза, гнилой
соломы, в старых трухлявых пнях, дуплах, в скоплениях прелых листьев, по
берегам речек и ручьёв
|
|
Эйзения Норденшельда
|
тёмно-вишнёво-красная
|
до 25-30
|
с 22-го по 28-й
|
в толще почвы, глубокие
ходы
|
|
Эйзениелла четырёхгранная
|
серовато-коричневая с
желтоватым оттенком
|
до 2,5-6
|
с 22-23 по 27-й
|
по берегам водоёмов, в воде
у берега
|
1.1.3 Экология дождевых червей
По особенностям экологии дождевых червей можно разделить на два типа: к
первому относятся черви, питающиеся на поверхности почвы, ко второму -
питающиеся в почве. В первом типе можно также выделить подстилочных червей,
которые живут в слое подстилки и ни при каких обстоятельствах (даже при
пересыхании или промерзании почвы) не опускаются в землю глубже 5-10
сантиметров. К этому же типу относятся почвенно-подстилочные черви, которые
проникают в почву глубже 10-20 сантиметров, но только при неблагоприятных
условиях, и норные черви, делающие постоянные глубокие ходы (до 1 метра и
более), которые они обычно не покидают, а при питании и спаривании высовывают
на поверхность почвы только передний конец тела. Второй тип можно разделить на
роющих червей, живущих в глубоком горизонте почв, и норных червей, имеющих
постоянные ходы, однако питающихся в гумусовом горизонте [14].
Подстилочные и роющие черви населяют места с переувлажнёнными почвами -
берега водоёмов, болотистые почвы, почвы влажных субтропиков. В тундре и в
тайге обитают лишь подстилочные и почвенно-подстилочные формы, а в степях -
только собственно почвенные. Наиболее благоприятные условия для
жизнедеятельности дождевых червей предоставляют им хвойно-широколиственные
леса: в этих зонах обитают все типы люмбрицид.
По образу жизни дождевые черви - ночные животные, и ночью можно
наблюдать, как они копошатся повсюду в большом количестве, оставаясь при этом
своими хвостами в норках. Вытягиваясь, они обшаривают окружающее пространство,
захватывают ртом (при этом глотка червя слегка выворачивается наружу, а затем
втягивается обратно) сырые опавшие листья и затаскивают их в норки.
Так как тело дождевых червей необыкновенно растяжимо, да к тому же
покрыто слегка загнутыми назад щетинками, они держатся в норке так крепко, что
вынуть их из земли, не разорвав на части, очень трудно. Большую часть дня черви
остаются в своём жилище. Исключением из этого правила являются больные особи,
заражённые личинками паразитической мухи. Такие животные бродят по поверхности
почвы среди дня и умирают вне своих нор.
Дождевые черви всеядны. Они заглатывают огромное количество земли, из
которой усваивают органические вещества, точно так же поедают они большое
количество всевозможных полусгнивших листьев, за исключением очень твёрдых или
обладающих неприятным для них запахом.
Полусгнившие или свежие листья втаскиваются червями через отверстия норок
на глубину 6-10 сантиметров и там поедаются. Дарвин наблюдал, каким образом
черви захватывают пищевые объекты. Если к поверхности земли в цветочном горшке
приколоть свежие листья, то черви будут стараться утащить их к себе в норки.
Обычно они отрывают маленькие кусочки, захватывая край листа между выдающейся
верхней и нижней губой. В это время толстая мощная глотка выпячивается вперёд и
тем самым создаёт верхней губе точку опоры. Если червь натыкается на плоскую
большую поверхность листа, он действует по-другому. Передние кольца туловища
немного втягиваются в последующие, за счёт чего передний конец тела
расширяется, становится тупым с небольшой ямкой на конце. Глотка подаётся
вперёд, прижимается к поверхности листа, а затем, не открепляясь, оттягивается
назад и слегка расширяется. В результате, в ямке на переднем конце тела,
приложенной к листу, образуется «вакуум». Глотка действует как поршень, и червь
очень прочно присасывается к поверхности листа. Жилки листа червь никогда не
трогает, а высасывает нежные ткани листьев [18].
Черви используют листья не только в пищу, но и затыкают ими входы в
норки. С этой целью они также тащат в норы кусочки стеблей, завядшие цветки,
обрывки бумаги, перья, клочки шерсти. Иногда из норы червя торчат пучки
листовых черешков или перьев. Листья, втащенные в норки червей, всегда смяты
или сложены в большое число складок. Когда втаскивается следующий лист, он
помещается снаружи от предыдущего, все листья плотно складываются и
сдавливаются друг с другом. Иногда червь расширяет отверстие своей норки или
делает рядом другую, чтобы набрать ещё больше листьев. Промежутки между
листьями черви заполняют влажной выброшенной из их кишечника землёй таким
образом, что норки совершенно закупориваются. Такие закупоренные норки особенно
часто встречаются осенью перед зимовкой червей. Листьями выстилается верхняя
часть хода, что препятствует соприкосновению тела червя с холодной и мокрой
землёй у поверхности почвы [14].
Дарвин описал также способы выкапывания норок дождевыми червями. Они
делают это либо раздвиганием земли во все стороны, либо заглатыванием её. В
первом случае червь просовывает узкий передний конец тела в щели между
частицами земли, затем вздувает и сокращает его, и тем самым частицы почвы
раздвигаются. Передний конец тела работает, как клин. Если земля или песок
очень плотные, утрамбованные, червь не может раздвинуть частицы почвы и
действует другим способом. Он заглатывает землю, и, пропуская её через себя,
постепенно погружается в грунт, оставляя за собой растущую кучку экскрементов.
Способность поглощать песок, мел и другие совершенно лишённые органики
субстраты является необходимым приспособлением на тот случай, когда червь,
погружаясь в почву от излишней сухости или холода, оказывается перед
неразрыхлёнными плотными слоями грунта [18].
Норки червей идут или вертикально, или немного вкось. Практически всегда
они выстланы изнутри тонким слоем чёрной переработанной животным земли. Комочки
земли, выбрасываемой из кишечника, утрамбовываются по стенкам норки
вертикальными движениями червя. Образованная таким образом выстилка становится
очень твёрдой и гладкой и тесно прилегает к телу червя, а у загнутых назад
щетинок есть прекрасные точки опоры, что позволяет червю очень быстро двигаться
в норке вперёд и назад. Выстилка, с одной стороны, укрепляет стенки норки, с
другой стороны, предохраняет тело червя от царапин. Норки, ведущие вниз,
заканчиваются обычно расширением, или камерой. Здесь черви проводят зиму,
поодиночке или сплетаясь в клубок по нескольку особей. Норка обычно выстлана
мелкими камешками или семенами, что создаёт прослойку воздуха для дыхания
червей.
После того, как червь заглатывает порцию земли, независимо от того,
сделано это для питания или для прокапывания хода, он поднимается к
поверхности, чтобы выбросить из себя землю. Выброшенная земля пропитана
выделениями кишечника и вследствие этого становится вязкой. Высохнув, комочки
экскрементов затвердевают. Выбрасывается земля червём не хаотично, а поочерёдно
в разные стороны от входа в нору. Хвост при этом работает, как лопата. В
результате вокруг входа в норку образуется своеобразная башенка из комочков
экскрементов. Такие башенки у червей разных видов имеют разную форму и высоту.
Это может служить важным систематическим признаком в определении видов дождевых
червей.
Когда червь высовывается из норки для выброса экскрементов, он вытягивает
вперёд свой хвост, если же для собирания листьев, выставляет голову.
Следовательно, черви обладают способностью переворачиваться в своих норках.
Черви не всегда выбрасывают экскременты на поверхность почвы. Если они находят
какую-то полость, например, около корней деревьев, в недавно вскопанной земле,
то откладывают свои экскременты туда. Легко заметить, что пространство под
камнями или упавшими стволами деревьев всегда заполнено мелкими катышками
экскрементов дождевых червей. Иногда животные заполняют ими полости своих
старых норок.
Дождевые черви в истории образования земной коры играли гораздо более
важную роль, нежели это может казаться на первый взгляд. Почти во всех влажных
местностях они многочисленны. Вследствие роющей деятельности червей
поверхностный слой почвы находится в постоянном движении. В результате этого
«перекапывания» частицы почвы перетираются друг о друга, новые слои грунта,
выносимые на поверхность, подвергаются действию углекислоты и гумусовых кислот,
что способствует растворению многих минеральных веществ. Образование гумусовых
кислот обусловлено перевариванием дождевыми червями полуразложившихся листьев.
Кроме того, проходя через кишечный тракт червей, земля и растительные остатки
склеиваются кальцитом - производным углекислого кальция, выделяемого
известковыми желёзками пищеварительной системы червей. Спрессованные
сокращениями мышц кишечника экскременты выбрасываются наружу в виде очень
прочных частиц, которые размываются значительно медленнее, чем такой же величины
простые комочки земли и представляют собой элементы зернистой структуры почвы.
Количество и масса экскрементов, образуемых ежегодно дождевыми червями,
огромны. За сутки каждый червь пропускает через свой кишечник количество земли,
примерно равное весу его тела, то есть 4-5 граммам. Ежегодно дождевые черви
выбрасывают на поверхность земли слой экскрементов толщиной 0,5 сантиметра.
Таким образом, черви наилучшим образом подготавливают почву для
произрастания растений: они разрыхляют её так, что не остаётся комочка крупнее,
чем они могут проглотить, облегчают проникновение в почву воды и воздуха.
Затаскивая листья в свои норы, они измельчают их, частично переваривают и
смешивают с земляными экскрементами. Равномерно перемешивая почву и
растительные остатки, они готовят плодородную смесь, подобно садовнику. Корни
растений свободно продвигаются в почве по ходам дождевых червей, находя в них
богатый питательный гумус. Нельзя не удивиться тому, что весь плодородный слой
уже прошёл через тела дождевых червей и через несколько лет снова пройдёт через
них.
Учёным
удалось выделить из тканей червей ферменты, которые обладают мощными
обеззараживающими и очистительными свойствами. Эти натуральные экологически
чистые продукты уже используются для очистки труб и аппаратов в пищевой
промышленности, для стирки, как моющие средства
<#"698743.files/image012.gif">
Рис.
12. Эйзения Малевича (Eisenia malevici)

Рис.
13. Эйзения салаирская (Eisenia salairica)
1.1.4 Роль
дождевых червей в процессах почвообразования
Влияние дождевых червей на проветривание и дренаж почв. Наличие ходов дождевых червей в
почве изменяет её свойства. Черви создают благоприятные условия для
проникновения в почву воздуха и воды, составляющие непременные условия для
жизни бактерий и грибков, деятельность которых играет ведущую роль в снабжении
корневых систем высших растений необходимыми для них веществами: азотом,
фосфором, калием и другими веществами. Дождевые черви содействуют осуществлению
существенного звена в процессе круговорота азота, облегчая циркуляцию воздуха в
почве и проникновение его в глубокие почвенные слои.
Полости, которые проделывают дождевые черви, представляют собой основные
места обитания разных групп мелких почвенных животных, принимающих участие как
в образовании перегноя, так и в его дальнейшей обработке.
Почвы, населённые дождевыми червями, обычно обильно пронизаны их ходами.
Стенки ходов черви покрывают слоем слизи и испражнений, поэтому эти стенки с
большим трудом поддаются разрушению водой [29].
В степных засушливых районах растениям приходиться добывать влагу с больших
глубин и корням, чтобы достигнуть воды, необходимо пробиваться через толщу
совершенно высохшего грунта. Как установлено Г.Н. Высоцким, корни дорастают до
водоносных слоёв, пользуясь ходами червей. На глубине 2 м нет ни одного корня,
который бы пробил себе дорогу самостоятельно; они идут внутри ходов дождевых
червей. Часто корни спаиваются вместе внутри хода, так как они оказываются
сдавленными окружающим их сухим грунтом [15].
Таким образом, деятельность червей обеспечивает важнейшие факторы
почвенного плодородия - аэрацию и дренаж. Невентилируемые и недренируемые почвы
лишены червей и агрономически очень низкого качества.
Влияние дождевых червей на перемешивание земли и вынос её на
поверхность. Черви
не только дренируют почву. Черви играют немалую роль в процессах перемешивания
земли и её выноса на поверхность. После прохождения почвы через кишечник червей
комочки почвы выбрасываются в виде копролитов (от. греч. kopros - навоз
и lithos - камень). Копролиты представляют собой сферические или
удлинённые комочки земли размером 1-5 мм. У свежевыброшенных копролитов гладкая
поверхность; они могут склеиваться друг с другом в агрегаты размером до 20 мм и
более. Копролиты выбрасываются червями в виде кучек высотой 3-15 мм,
закрывающих обычно наружное отверстие хода червя, хотя значительная часть
копролитов откладывается и в подземных ходах [17].
Перемешивание слоёв почвы идёт не только благодаря вынесению частиц почвы
с глубины на поверхность, но и за счёт перемещения частиц из поверхностных
слоёв в глубину. Это может происходить путём стекания вместе с водой
размоченного дождём гумусного слоя по ходам дождевых червей, а также
непосредственно путём откладывания испражнений в подземных ходах, подчас на
большой глубине. Следует заметить, что перед свёртыванием в клубок при впадении
в спячку в зимних и летних камерах обязательно опоражнивается кишечник, причём
это происходит обычно неподалёку от камер, то есть на значительной глубине
[26].
Таким образом, благодаря дождевым червям происходит перемешивание слоёв
почвы. Заглатывание червями почвы и вынос её на поверхность представляет собой
непрерывно идущий процесс образования нового поверхностного слоя, в котором
частицы почвы с разных глубин оказываются тщательно перемешанными друг с
другом.
Влияние дождевых червей на структуру и химический состав
почв. Почва, проходя
через кишечники дождевых червей, не только перемещается с одного места на
другое, но и качественно меняется. Земля, проглоченная червём, перетирается в
его желудке с листьями и другими растительными остатками, а также подвергается
химической обработке при помощи веществ, выделяемых железами разных отделов
кишечника. В результате, получается мелкая однородная пищевая кашица, из
которой некоторая часть растворённых веществ всасывается клетками кишечника. Червь
утилизирует, конечно, очень небольшую часть проглоченных веществ. Дождевые
черви являются одновременно и потребителями, и производителями гумуса почв
[30].
Более важны косвенные последствия внесения дождевыми червями в почву
органических веществ. Химическими анализами подтверждено накопление в
испражнениях червей аммиака, нитратов, фосфорной кислоты, кальция и магния.
Существенно также накопление в кишечнике червей кальция в виде биогенного
кальцита. Присутствие биогенного кальцита способствует нейтрализации кислот в
почве и изменяет её структурные свойства.
Важнейшее значение дождевых червей состоит в придании почве зернистой
структуры. Механический анализ копролитов показывает, что по сравнению с
исходной почвой в них содержится большее количество мелких, пылеватых частиц.
Однако обнаружить их можно только после искусственного разрушения структурных
отдельностей, в которые они слипаются в задних отделах кишечника. Отдельные
комочки испражнений могут слипаться друг с другом. Многочисленные опыты подтверждают
образование из мелкой почвы довольно крупных отдельностей неправильной формы.
Главная особенность таких структурных отдельностей состоит в их высокой
водопрочности, то есть способности противостоять размыванию водой. Очень
вероятно, что это объясняется наличием каркаса из неразложившихся волокон
растений. К тому же почвенные зёрнышки цементируются кристаллами окиси кальция
и его углекислой соли [16].
Итак, дождевые черви придают почве зернистую структуру и изменяют её
химический состав.
1.1.5
Калифорний красный червь и владимирский «старатель»
Калифорнийский красный червь был выведен в университете штата Калифорния
в 1959 году американским врачом Т. Барретом (рис. 14). На собственной ферме он
занимался разведением червей с целью повышения доходности своего хозяйства. Он
исходил из понимания необходимости полнейшей утилизации всех органических
отбросов, получающихся в хозяйстве, то есть отходов кухни, сада, огорода, а
также опавшей листвы и тому подобных органикосодержащих отходов и использования
их в качестве корма дождевым червям. Червей он выращивал в деревянных ящиках,
заполненных землёй, навозом и отходами. Красный калифорнийский червь отличается
от других видов способностью перерабатывать все виды органики, а также очень
высокой плодовитостью (более чем в 100 раз) и долгожительством
(продолжительность жизни их составляет более 16 лет). Важной особенностью
калифорнийского красного червя была потеря инстинкта покидать место обитания
даже при неблагоприятных условиях окружающей среды.
Результаты этих исследований не остались незамеченными. При помощи
калифорнийских червей вот уже 15 лет перерабатывают мусор в Германии, Франции,
Венгрии, Дании, Италии. Калифорнийский червь поедает опилки, гнилые овощи, ил
сточных вод, а также отходы пищевых предприятий, кости, внутренности животных.

Рис. 14. Красный калифорнийский червь
В России разведением дождевых червей занимались с начала XX века. К этому делу внимание привлёк
эффект роста урожайности выращиваемых культур в лабораторных условиях.
Развернувшаяся в СССР индустриализация и химизация вызвала пренебрежение
к органической системе земледелия и к дождевым червям, как её главной составной
части. Практически до середины 80-х годов никаких исследований по биотехнологии
переработки навоза (и другой органики) в гумусное удобрение (биогумус,
червекомпост) с помощью технологических дождевых червей не проводилось.
Исследования впервые были осуществлены Анатолием Михайловичем Игониным во
Владимирском государственном педагогическом институте (ВГПИ) в 1984 г. по теме:
«Разработка методики культивирования местных разновидностей дождевых
(компостных) червей с целью переработки навоза (и другой органики) в гумусное
органическое удобрение». Он вывел свою технологическую породу компостных червей
«старатель» (рис. 15), получил патент, на основе которого сейчас работает ОАО
«Международная научно-производственная корпорация «Грин-ПИКъ».

Рис. 15. Черви технологической породы «старатель» и их коконы
Исследования проводили в лабораторных культиваторах: в 50-литровых
алюминиевых кастрюлях - наплитных котлах (80 шт.), размещённых на стеллажах в
отапливаемых помещениях, а также в бытовых 250-литровых эмалированных ваннах
(50 шт.), размещённых в специально оборудованных залах отапливаемого
подвального помещения. Такое оборудование позволило провести многовариантные
исследования по культивированию червей и исследованию продуктов этой
биотехнологии. Параллельно проводились исследования в открытом грунте в течение
пяти лет. Это дало возможность определить все необходимые параметры по
разведению (культивированию) червей и составить регламенты опытно-промышленной
технологии переработки навоза (и другой органики) в гумусное органическое
удобрение (биогумус, червекомпост) с помощью специализированных
(технологических) дождевых червей для закрытых помещений (тепличных хозяйств) и
для открытых грунтовых и бетонированных площадок [21].
Успех биотехнологии связывается прежде всего с подготовкой кормовой базы
для быстроразвивающейся популяции червей. Компост для червей - их дом и пища.
Поедая, они превращают его в гумусное органическое удобрение. Такого корма для
размножающихся червей требуется много, и он должен отвечать определённым
требованиям. Несоблюдение их может замедлить развитие червей или даже погубить
их.
Для производства биогумуса в России в промышленных масштабах в основном
используют красных калифорнийских червей. Продолжительность жизни их составляет
до 16 лет, тогда как дикие черви живут до 4 лет. За время жизни красный
калифорнийский червь даёт до 20 тысяч особей потомства, то есть около 1500
червей в год. Длина взрослого червя 5-8 см, диаметр - 3-5 мм, вес - 0,5-1,0 г.
В природе черви питаются отмершими частицами растений, перегноем почвы. В
искусственных условиях необходима подготовка субстрата, в качестве которого
используются различные виды органических отходов и их смеси.
Культивируемые компостные черви, в отличие от диких сородичей, имеют
определённый ритм жизнедеятельности. В толще субстрата они погружаются на
глубину 30-40 см, передвигаясь по вертикали и горизонтали. В поверхностном слое
(0-5 см) они питаются, в среднем - откладывают коконы, в нижнем - испражняются.
Для успешного разведения червей необходимо соблюдение определённых
требований к условиям среды их обитания:
) оптимальная температура для размножения и развития червя от +19 до +25 ºС (при температуре выше +38 ºС и ниже +4 ºС черви погибают);
) влажность среды от 70 до 80%. Хотя черви и обладают способностью
переносить высокий процент потери воды из организма, однако если влажность
субстрата длительное время ниже 35%, черви могут погибнуть;
) оптимальная реакция среды - нейтральная, pH=7,0. Допускается использование компоста с pH от 6,0 до 8,0. При реакции среды
ниже pH=5,5 (кислая) и выше pH=8,5 (сильнощелочная) черви могут
погибнуть;
) при высокой влажности для дыхания червей необходимо обеспечение доступа
кислорода. С этой целью уплотнившийся субстрат следует периодически рыхлить,
стараясь не перемешивать при этом слои [21].
1.1.6 Качественная и количественная характеристика биогумуса
Биогумус - продукт переработки навоза, торфа красными калифорнийскими
червями (таблица 2, рис. 16). Ценнейшее, широко известное органическое
удобрение продлённого комплексного действия, содержащее кроме элементов питания
растений стимуляторы роста, ферменты, антибиотики, аминокислоты и обильную
полезную микрофлору. Благодаря его свойствам биогумус используют не только как
удобрение, но и как средство восстановления истощённых и мёртвых почв. Внесение
его в почву в весьма умеренных дозах (1-3 кг на м2) значительно повышает
урожайность культур: зерновых - на 10-25%, овощных - на 25-40%. Качество
продукции также возрастает. Особо следует отметить высокую технологичность
биогумуса для внесения в почву, а также его способность значительно ускорять
разложение органики, внесённой совместно с ним.
Таблица 2 - Качественная и количественная характеристика товарного
биогумуса в соответствии с ТУ 0392-001-24620865-02
|
Массовая доля влаги, %
|
25 - 60
|
|
Массовая доля
органического вещества, %
|
30 - 70
|
|
Гумус, %
|
10 - 25
|
|
Гуминовые кислоты, %
|
2,5 - 10
|
|
Фульвокислоты, %
|
1.3
|
|
Кислотность, рН
|
6,8 - 7,2
|
|
Общий азот, %
|
1 - 4
|
|
Общий фосфор, %
|
1 - 5
|
|
Общий калий, %
|
0,5 - 2
|
|
Общий магний, %
|
0,5 - 1,5
|
|
Общее железо, %
|
0,4 - 2
|
|
Общая сера, %
|
0,1 - 0,5
|
|
Марганец, млг/кг
|
250 - 1000
|
|
Цинк, млг/кг
|
50 - 600
|
|
Медь, млг/кг
|
15 - 250
|
|
Бор, млг/кг
|
15 - 250
|
Объём нетто - 2,5 л.

Рис. 16. Биогумус (вермикомпост) - продукт переработки красных
калифорнийских червей
О предприятии-производителе: ОАО «Сибирский торф» создано в апреле 1993
г. Учредителями ОАО «Сибирский торф» являются: СИБИРСКИЙ НИИ ТОРФАСО АН РФ г.
Томск, «РОСНАУЧИННОВАЦЕНТР» г. Москва, физические лица. В потенциале ОАО
«Сибирский торф» технологии по переработке торфа: производство стимулятора
роста растений «Гумат натрия +NPK»,
высокоэффективное органическое удобрение «вермикомпост» (биогумус) - продукт
переработки органики калифорнийскими червями, энтеросорбент ЭСТ-1, рассадочные
и цветочные грунты на основе низинного торфа, с добавлением вермикомпоста,
природного цеолита, минеральных удобрений и микроэлементов, органические удобрения.
1.2 Сорт
яровой пшеницы «Новосибирская-29»
В Сибирском НИИ растениеводства и селекции был выведен уникальный сорт
яровой пшеницы, получившей название Новосибирская-29. Новосибирские учёные
селекционировали эту зерновую культуру в течение 14 лет. «Новосибирская-29»
имеет крупные зёрна, повышенное содержание белка и клейковины. Главные её
достоинства - урожайность, морозоустойчивость, раннее созревание.
Продуктивность составляет 50 центнеров с гектара. По словам председателя
Сибирского НИИ растениеводства и селекции, кандидата наук Юрия Христова,
Новосибирская-29 - большое достижение новосибирских учёных. Государственные
испытания элитного растения начаты.
1.3
Характеристика промышленных отходов
Изучаемыми промышленными объектами явились: отходы железорудного
обогащения хвостохранилища Абагурской аглофабрики, шламовые отходы ЗСМК и
золошлаковые отходы Томь-Усинской ГРЭС.
1.3.1
Отходы железорудного обогащения Абагурской аглофабрики
Согласно классификации промышленных отвалов по В.В. Тарчевскому (Тарчевский,
1970) [28] данный промышленный объект по происхождению относится к отвалам
перерабатывающей промышленности наливного типа; по возрасту - средневозрастной
(свыше 20-ти лет); по форме - чашевидный; по высоте - средний (до 25-ти
метров); по механическому составу поверхностного субстрата - крупнопылевидный и
пески (частицы до 0,1 мм); по кислотности (рН) - кислый; по утилизации -
неиспользуемый.
Абагурская агломерационная фабрика - крупный промышленный объект,
деятельность которого в значительной степени осложняет и ухудшает экологические
условия окружающей среды [32]. Её обширные хвостохранилища, заполнены песчаными
субстратами, постоянно подвергаются водной и ветровой эрозии, тем самым,
загрязняя атмосферу и грунтовые воды (рис. 17). По этой причине возникла
необходимость быстрейшего их биологического закрепления и организации на их
месте рекреационных угодий. Отходы производства - хвосты магнитной сепарации
железной руды в количестве до 2,2 миллионов тонн в год направляются в
хвостохранилища. В настоящее время три хвостохранилища занимают площадь более
350 га. Хвостохранилище №3 действующее. Хвостохранилище №1 и №2 представляют
собой два обособленных плато высотой до 20 метров общей площадью около 190 га.
Запас складированных в них хвостов оценивается примерно в 100 миллионов тонн.
По своему химическому составу и свойствам хвосты могут быть отнесены к
промышленному сырью с широким спектром возможного применения. В настоящее время
исследуется технология извлечения полезных элементов из складированных и текущих
хвостов методами гравитационного обогащения, плазменной обработки.
Крупнотоннажная переработка на протяжении 20 лет существования хвостохранилища
№1 не организована. Периодически хвосты используются в небольших количествах в
качестве заменителя песка в дорожном строительстве.

Рис. 17. Отходы железорудного обогащения Абагурской агломерационной
фабрики
Хвостохранилище заполнено при помощи гидротранспорта, что привело к
дифференциации материала по гранулометрическому составу.
В почвенно-экологическом отношении материал отработанных хвостохранилищ
характеризуется очень высокой неоднородностью практически всех химических,
физико-химических, агрофизических и агрохимических параметров. Эта
неоднородность определяется спецификой технологии формирования гидроотвалов,
которая дифференцирует материал как по площади гидроотвала так и в его толще.
Высокая плотность - 1,7 г/см3 и выше, делает этот субстрат практически
корненепроницаемым, резко снижает объём порового пространства, количества пор и
водопроницаемости. По этой причине при рекультивации хвостохранилищ необходимо
введение специального технологического элемента, снижающего эту плотность,
например, смешивание с другими менее плотными субстратами.
Вследствие мелкофракционного состава и значительных масштабов занимаемой
ими территории (350 га), субстрат хвостохранилищ практически полностью лишён
растительности и подвержен ветровой эрозии, что оказывает негативное
воздействие на биогеоценоз близлежащих территорий [4]. В районе посёлка Елань
годовое выпадение пыли составляет 409 г/м2, что более чем в 200 раз превышает
фоновый показатель для лесостепной зоны (2 мг/м2). В радиусе 8 км вокруг
Абагурской аглофабрики отмечено загрязнение почв, в том числе железом в 3-3,5
раза выше фона (Романенко, 1992) [27]. Среди жителей посёлка Елань отмечена
высокая заболеваемость силикозом.
Субстрат хвостохранилища относится к категории сильно засолённых,
фитотоксичных. При этом степень фитотоксичности достигает очень высоких
значений. Факторами фитотоксичности выступают хлориды и сульфаты. Долевое
участие этих солей примерно одинаково. Хвосты отнесены к 4 классу токсичности.
Основными причинами препятствующими естественному зарастанию поверхности
хвостохранилища, являются:
фитотоксичность, обусловленная засолением поверхности;
высокая плотность сложения субстрата;
низкое содержание элементов питания растений;
неблагоприятные микроклиматические условия, такие как высокая температура
в летний период, незначительное накопление снегового покрова зимой, ветровая
эрозия, то есть засекание молодых побегов и листьев растений песчаным
материалом хвостохранилища [2].
Фитотоксичность пород в сочетании с их высокой плотностью - главная
причина длительного существования техногенной пустыни Абагурского хвостохранилища.
Для восстановления почвенно-растительного слоя необходима технология
рекультивации, позволяющая улучшить условия на поверхностях хвостохранилища и
обеспечить долгосрочное функционирование фитоценоза в данных микроклиматических
условиях. Успешная рекультивация возможна при создании органо-минеральных
смесей на его поверхности в процессе подготовительного этапа и последующей
биологической рекультивации, то есть создания устойчивых культурфитоценозов для
предотвращения эрозии. Известно, что наиболее рациональным способом
восстановления органической составляющей отвалов является размещение на их
поверхности плодородного слоя земли, снятого при строительстве новых отвалов.
Этот способ возможен для рекультивации склонов хвостохранилища №2 путём
размещения почвенного слоя с территории хвостохранилища №3, но не используется
на всех площадках, требующих рекультивации, из-за ограниченного количества
необходимого материала.
Таким образом, создание травяного покрова на поверхности хвостохранилища
коренным образом улучшит ситуацию с обеспечением снегонакопления зимой, что в
совокупности с фактором присутствия органического субстрата повысит
эффективность восстановления почвенно-растительного слоя на поверхности
хвостохранилища.
Без проведения рекультивационных мероприятий создание устойчивого
фитоценоза и формирование в субстрате хвостохранилища корнеобитаемого слоя,
препятствующего развитию водной и ветровой эрозией, невозможно. Установлена
перспективность использования ОСВ (осадка сточных вод) в качестве субстрата, существенно
улучшающего химико-физические свойства пород. Практически на всех опытных
площадках отмечается заметное снижение напряженности режимов функционирования
сформированных культурфитоценозов. В результате внесения ОСВ происходит
улучшения питательного режима субстратов хвостохранилища по всему комплексу
элементов зольного питания растений. Во всех вариантах способов размещения ОСВ
достигнут положительный эффект - рост урожая с увеличением нормы внесения ОСВ
[7].
Созданы рекультивированные участки на отходах железорудного обогащения и
металлургического шлака. Проведён мониторинг опытных участков, заложенных в
1997 и 1998 гг. на территории хвостохранилища Абагурской аглофабрики.
Установлено, что через 2-3 года создадутся условия для становления почвенного
микробоценоза и формирования устойчивого культурфитоценоза. Исследованы
микроклиматические условия созданных местообитаний. Установлено влияние опытных
участков на самозарастание прилегающих территорий отвалов.
.3.2 Золошлаковые отходы Томь-Усинской
ГРЭС
Изучаемый объект относится (Тарчевский, 1970) [28] по происхождению к
отвалам перерабатывающей промышленности наливного типа; по возрасту - к старым;
по форме - к чашевидным; по высоте - к низким; по механическому составу
поверхностного субстрата - к крупнопылевидным (частицы до 0,1 мм); по
кислотности - к нейтральным (7,15); по утилизации - к неиспользуемым.
Томь-Усинская ГРЭС работает на окисленных, влажных и многозольных углях «СС»
открытой добычи с теплотой сгорания около 4000 ккал/кг при рабочей зольности
20-35%. При суточной норме потребления угля 10000 тонн на золоотвал и в
атмосферу выбрасывается более 2500 тонн золошлакового материала и зольной пыли.
В настоящее время золоотвалы (действующий и недействующий) Томь-Усинской ГРЭС
занимают площадь 600 га (рис. 18). Их рекультивация с использованием
нетрадиционных почвообразующих материалов имеет большое экологическое и
социальное значение [11].
По физическому строению зола каменного угля представлена рыхлой,
распыленной массой серого цвета. Присутствие оксидов железа и отсутствие
органики снижает отражательную способность золы. Влажность её сильно зависит от
состояния погоды. Поэтому, в течение вегетационного режима для растений
складывается крайне неблагоприятный температурный и водный режимы с резкими
колебаниями обоих показателей.

Рис. 18. Золошлаковые отходы Томь-Усинской ГРЭС
Химический состав золы представлен в основном алюмосиликатами. В золе
мало серы и железа, так как Кузнецкие угли отличаются малым содержанием этих
элементов. Значение рН её водной вытяжки составляет 7,5-7,6, что вполне создаёт
благоприятные условия для корневого питания растений. В этом отношении
заслуживает внимания опыт выращивания сельскохозяйственных культур на
золоотвалах Приморской ГРЭС без внесения каких-либо почвоулучшителей.
Недействующий золоотвал Томь-Усинской ГРЭС находится в г. Мысках
Кемеровской области. Он расположен на надпойменной террасе реки Томь между
площадкой ГРЭС (960 м от главного корпуса) и близлежащей деревней Безруково.
Золошлаковый материал включает в себя фракции размером менее 0,25 мм - золу,
более крупные относят к шлакам. Котлован заполнен золой в 1963 г. (начат в 1957
г.) и представляет собой практически плоскую поверхность, сформированную
гидронамывом золы от сжигания каменного угля. Ёмкость котлована - 1,8 миллионов
м3. Общая площадь нарушенной территории - 39 га. Поверхность золоотвала
приподнята над окружающей территорией на высоту 2-2,5 м. Первоначальная
обваловка золоотвала сохранилась практически по всему его периметру.
На участках, отсыпанных шлаком, растительность практически отсутствует.
Более или менее развитый растительный покров сформировался на поверхности
золоотвала и на свалках промышленных и бытовых отходов. Однако любое
механическое повреждение дернины надолго оголяют поверхность золы, и позволяет
развиваться эрозионным процессам [12].
Традиционно для рекультивации используются природные материалы -
плодородный слой почв, глина, суглинки. По оценке специалистов Кузбасс
относится к регионам с низкой обеспеченностью природными материалами для
рекультивации, что делает актуальным вовлечение отходов, содержащих
органическое вещество. Наиболее эффективные результаты по восстановлению
плодородия почв достигается при использовании специальных препаратов.
При наличии собственных отходов от ОСВ, донных отложений иловых
образований дренажных канав целесообразно исследовать их пригодность для
рекультивационных целей. Такие отходы, как правило, характеризуются низкой
плотностью, высокой водонепроницаемостью и водоудерживающей способностью.
Золоотвалы ГРЭС являются постоянно действующим источником поступлений
вредных веществ в окружающую среду по двум основным факторам воздействия:
выветривание пылевидных частиц в результате ветровой эрозии в атмосферу,
на почву и в поверхностные водоисточники прилегающей территории;
вымывание водорастворимых соединений в наземные и подземные водоносные
потоки [5].
Предлагаемая технология рекультивации обеспечивает:
прекращение выветривания пылевидных частиц в результате ветровой эрозии в
атмосферу, на почву и в поверхностные водоисточники прилегающей территории за
счёт задернения пылящей поверхности;
прекращение вымывания водорастворимых веществ в наземные водные объекты
за счёт задернения поверхности, подвергаемые водной эрозии;
существенное сокращение миграции соединений в подземные водоносные потоки
в результате стабилизации физико-химических процессов, а также за счёт
задернения поверхности.
При выборе направления и способа рекультивации следует учитывать ряд
факторов, среди которых наиболее важными являются стоимость работ и оценка
экологической эффективности.
1.3.3
Шламовые отходы ЗСМК
Изучаемый объект (Тарчевский, 1970) [28] по происхождению относится к
отвалам перерабатывающей промышленности наливного типа; по возрасту - к свежим;
по форме - к полям нарушений с разнообразным мезо- и микрорельефом; по высоте -
к средним; по механическому составу поверхностного субстрата - к крупномерным
(камни и глыбы свыше 5 см); по кислотности - от нейтральной (6,5) до
слабощелочной (8,3); по утилизации - к неиспользуемым.
Шламохранилище ЗСМК является накопителем шламовых отходов предприятий,
находящихся в промышленной зоне Западно-Сибирского металлургического комбината
и расположено на поверхности надпойменной террасы реки Томь (рис. 19). После
транспортировки шламов трубопроводами в шламонакопители происходит высыхание
пульпы на солнце, что увеличивает сопротивление материала сдвигу и, в конечном
счёте, его пылеунос. Наиболее важными с точки зрения охраны окружающей среды
являются вопросы образования пыли, разрушение шламов под действием
обезвоживания, устойчивость к различным естественным средам (водная, ветровая
эрозия) и возможность последующей рекультивации.

Рис. 19. Шламовые отходы ЗСМК
Общая площадь составляет более 300 га при высоте около 25 м. Со всех
сторон шламохранилище окружено дамбой, сложенной смесью крупнодисперсного
отсева отходов углеобогащения и шлака конвертного производства. Дамба
представляет собой трапециевидное в разрезе сооружение, внешний склон которого
террасирован. Всего на склонах дамбы сформировано две террасы, плоская
поверхность которых используется для прокладки технологических дорог.
Одновременно эти террасы выполняют защитную роль, охраняя дамбу от разрушения
водно-эрозионными и дефляционными процессами, хотя при этом их бровки и крутые
склоны продолжают достаточно интенсивно разрушаться. Для закрепления бровок
всей поверхности террас требуется, следовательно, применение рекультивационных
методов, в частности методов биологической рекультивации, способность создать
условия для развития фитоценозов, почвообразования, сопровождающегося
формированием прочной дернины. Ширина террас колеблется в пределах 10-40
метров. Борта террас в настоящее время не закреплены - их крутизна определяется
углом естественного откоса - и по этой причине подвержены разрушению
водно-эрозионными и дефляционными процессами.
Террасы, расположенные в нижней трети склона дамбы, испытывают
периодический подпор водами, фильтрующимися сквозь тело дамбы и транзитом
проходящими в водоотводной канал, окружающий дамбу. При отсутствии в породах,
слагающих дамбу и данную террасу физической глины и, соответственно,
капиллярной каймы, достигающей поверхности, это не приводит не только к
переувлажнению верхних слоёв породы, но даже к их увлажнению. Эта причина, как
и сильное переуплотнение породы, в значительной степени препятствуют развитию
фитоценозов и почвообразованию. Постоянное присутствие на небольшой глубине в
породах террасы грунтовых вод представляет собою потенциальную экологическую
опасность, поскольку создаются условия для развития в толще пород анаэробных
восстановительных процессов. Эта опасность остаётся потенциальной до тех пор,
пока в системе не появится свежее органическое вещество, способное сильно
активизировать восстановительные процессы. Такое вещество будет образовано при
проведении биологической рекультивации, особенно с использованием ОСВ в
качестве почвоулучшителя. Усиление восстановительных процессов приведёт к
повышению растворению токсичных элементов, формированию с ними новых токсичных
соединений из водорастворимых продуктов, поступающих в толщу террасы из
гидроотвала. Эти соединения поступят в водоотводной канал и конечную зону
аккумуляции дренажных вод.
Таким образом, проведение широкомасштабных биорекультивационных работ,
особенно с использованием ОСВ, необходимо проводить только на основании
специального проекта, предусматривающего применение профилактических мер против
появления негативных экологических последствий.
Проведение полевых экспериментов на шламохранилище ЗСМК показало, что
использование ОСВ в достаточном количестве позволит улучшить агрохимические
параметры субстрата в сформированном корнеобитаемом слое произрастаемых
растений [3, 6, 9, 10, 13].
Повышение содержания ОСВ от 10 до 20 см позволяет увеличить в
корнеобитаемом слое фракцию физической глины и водоудерживающую способность, а
также улучшить агрохимические параметры субстрата, что позволяет создать
условия для относительно стабильного функционирования фитоценоза, развития
почвообразования. Технологический приём двойного нанесения ОСВ общей мощностью
до 30 см способствует более равномерному распределению в корнеобитаемом слое
фракции физической глины и увеличению мощности слоя пород с удовлетворительными
параметрами субстрата по плотности и водоудерживающей способности, что
значительно сокращает зависимость фитоценоза от режима атмосферных осадков и
повышает устойчивость его развития и функционирования.
Нанесение на щелеванную поверхность террасы дамбы гидроотвала слоя обработанного
известью материала ОСВ обеспечивает хорошие воднофизические, физические и
физико-химические свойства субстрата в корнеобитаемом слое мощностью в 20 см.
Комбинирование ОСВ с суглинком, а также использование суглинка без ОСВ
обеспечивает относительно равномерное в пределах потенциального корнеобитаемого
горизонта распределение фракций физической глины и близкий к оптимальному
гранулометрический состав субстрата, его хорошую водоудерживающую способность,
сохранение значительно больших, по сравнению с предыдущими вариантами опытов,
запасов продуктивной влаги и, следовательно, меньшую зависимость фитоценоза от
режима выпадения дождей в течение вегетационного периода. Плотность такого
субстрата также близка к оптимальной. Мощность потенциального корнеобитаемого
слоя практически соответствует таковой в ненарушенных зональных почвах. В
созданных с использованием суглинка местообитаниях способны сформироваться и
устойчиво функционировать засухоустойчивые культурфитоценозы.
Снятие породы террасы дамбы гидроотвала до глубины 40 см; перепахивание
новой поверхности на глубину 30 см; отсыпка на перепаханную поверхность слоя
карбонатных суглинков, мощностью 20 см и слоя ОСВ, также мощностью 20 см;
последующее перепахивание субстрата на глубину 30 см является наиболее
эффективным из исследованных способов с точки зрения снятия лимитирующих
факторов, однако и наиболее технологически сложным. Отличается от всех
предыдущих отсутствием факторов, лимитирующих развитие культурфитоценозов и
почвообразования.
Породы, слагающие дамбу гидроотвала, состоят из крупнодисперсных фракций
с преобладанием частиц размерностью от 5 до 15 мм. Мелкозем и особенно фракции
физической глины практически отсутствуют. В петрографическом составе пород
террасы дамбы преобладают обломки алевролитов и аргиллитов. В небольшом
количестве встречается окатанная галька основных массивно-кристаллических
пород. Преобладание в петрографическом составе пород алевролитов и аргиллитов
создаёт потенциальные предпосылки накопления мелкозема в том числе фракций пыли
и физической глины, которые образуются при механической дезинтеграции
алевролитов и аргиллитов. Наблюдения показывают, что в верхних 10-15 см слоях
пород террасы вследствие чередования явлений увлажнения - иссушения,
прогревания - охлаждения, замерзания - оттаивания эти процессы идут. Здесь хотя
и в небольших количествах, но накапливаются тонкодисперсные фракции, в том
числе и физической глины. Одновременно в этих же слоях отмечается значительное
снижение плотности материала - от 1,8 г/см3 в нижних слоях до 1,4 - в верхних.
Все эти явления позитивного плана, однако процессы естественной дезинтеграции
идут чрезвычайно медленно, поэтому их практическая значимость невелика и
принимать их в расчёт при проектировании рекультивационных мероприятий нецелесообразно.
На глубине 15-20 см от поверхности структура, состав и свойства пород
сохраняются в первоначальном виде в течение десятилетий. Плотность пород здесь
достигает критических значений - 1,8 и более г/см3. Отсутствие в составе пород
тонкодисперсных фракций и особенно фракций физической глины, а так же очень
высокая плотность сложения материала - главная причина, препятствующая
появлению на террасе растительности, формированию фитоценоза, способствующего
развитию почвообразования и восстановлению необходимого комплекса
почвенно-экологических функций [8].
Породы террасы дамбы гидроотвала чаще всего бескарбонатные, однако,
пятнами встречаются и карбонатные. По этой причине реакция среды в них
колеблется от близкой к нейтральной (pH около 6,5) до слабощелочной (pH около
8,3). В составе пород отмечается присутствие небольшого количества
легкорастворимых солей. Общее их количество невелико и обычно не превышает
0,1%.
Итак, сведём данные о характеристиках промышленных отходов в
сравнительную таблицу 3.
Таблица 3 - Характеристика промышленных отходов (по классификации В.В.
Тарчевского, 1970)
|
Показатели
|
Отходы железорудного
обогащения шламохранилища Абагурской аглофабрики
|
Золошлаковые отходы
Томь-Усинской ГРЭС
|
Шламовые отходы ЗСМК
|
|
Происхождение
|
отвалы перерабатывающей
промышленности наливного типа
|
отвалы перерабатывающей
промышленности наливного типа
|
отвалы перерабатывающей
промышленности наливного типа
|
|
Возраст
|
средневозрастные (свыше 20
лет)
|
старые
|
свежие
|
|
Форма Высота
|
чашевидные средние (до 25
метров)
|
чашевидные
|
поля нарушений с
разнообразным мезо- и микрорельефом
|
|
|
низкие
|
средние
|
|
Механический состав
поверхностного субстрата
|
крупнопылевидные и пески
(частицы до 0,1 мм)
|
крупнопылевидные (до 0,1
мм)
|
крупномерные (камни и глыбы
свыше 5 см)
|
|
Кислотность (pH)
|
кислый
|
нейтральный (7,15)
|
от нейтрального (6,5) до
слабощелочного (8,3)
|
|
Утилизация
|
неиспользуемые
|
неиспользуемые
|
неиспользуемые
|
|
Химический состав
|
железо, хлориды, сульфаты
|
оксиды железа, сера,
алюмосиликаты
|
легкорастворимые соли
|
|
Токсичные свойства
|
фитотоксичность,
загрязнение почв железом
|
загрязнение атмосферы,
почвы и воды
|
фитотоксичность
|
1.4
Методика проводимых исследований
дождевой
червь вермикомпост утилизация
1.4.1
Условия проведения лабораторного эксперимента
Используется полевой (сбор отходов) и лабораторный методы. Промышленные
отходы смешивают с вермикомпостом в различных соотношениях (рис. 20).
. Вес субстрата (шламовых отходов, отходов железорудного обогащения,
золошлаковых отходов) - 85% (51 г), 70 % (42 г) и 100% (60 г).
. Содержание и вес вермикомпоста - 15% (9 г), 30% (18 г) и 0%.
. Варианты опыта: техногенный контроль (без внесения вермикомпоста, вес
субстрата 60 г): а) техногенный контроль - шламовые отходы (шлам), б)
техногенный контроль - отходы железорудного обогащения (хвосты), в) техногенный
контроль - золошлаковые отходы (зола); 15% вермикомпоста: г) 9 г вермикомпоста
и 51 г шламовых отходов, д) 9 г вермикомпоста и 51 г отходов железорудного
обогащения, е) 9 г вермикомпоста и 51 г золошлаковых отходов; 30%
вермикомпоста: ж) 18 г вермикомпоста и 42 г шламовых отходов, з) 18 г
вермикомпоста и 42 г отходов железорудного обогащения, и) 18 г вермикомпоста и
42 г золошлаковых отходов.
. В каждую из 9 чашек Петри высеиваются по 100 зерновок яровой пшеницы
«Новосибирская-29».
. Полив регулярный (около 30 мл на каждую чашку Петри).
. Температура - 23 ºС.
Рис. 20. Чашки Петри с вариантами опыта
1.4.2
Определение содержания хлорофилла в проростках злаков
Используется метод количественной оценки содержания пигментов. Берут
навеску сырых проростков массой 500 г и помещают в фарфоровую ступку, растирают
с 7 мл ацетона, фильтруют экстракт через бумажный фильтр, фильтрат промеряют
через синий светофильтр фотоэлектроколориметра. Полученные оптические
показатели сравнивают с калибровочной кривой и получают результат содержания
хлорофилла в мг/л.
1.4.3
Цитохимический анализ на содержание тяжёлых металлов
Используются цитохимический и микроскопический методы. С помощью лезвия
делают поперечный срез проростков. Срез помещают в каплю 5%-ного Na2S на предметном стекле и рассматривают под микроскопом при
120-тикратном увеличении. Фиксируют локализацию солей тяжёлых металлов
(кристаллы PbS чёрного цвета, CdS жёлтого или красного) в тканях.
После этого по той же методике проделывают тоже самое с 5%-ным раствором KY, где фиксируют локализацию солей
тяжёлых металлов (кристаллы йодида свинца жёлтого цвета) в тканях тех же
растений.
1.4.4
Определение видового состава почвенных микроорганизмов
В чашки Петри высеиваются культуры почвенных микроорганизмов на
питательную среду агар-агар. С помощью микроскопического и морфологического
методов определяется видовой состав почвенных микроорганизмов.
Глава 2.
Результаты исследования и обсуждение результатов
.1
Результаты исследований 3-го дня лабораторного эксперимента
Таблица 4 - Энергия прорастания и биометрические показатели проростков
пшеницы, %, мм (3-й день эксперимента)
|
Золошлаковые отходы
|
Шламовые отходы
|
Отходы
железорудногообогащения
|
|
1 вариант - Техногенный
контроль. 28%, 30 мм (плесень отсутствует)
|
1 вариант - Техногенный
контроль. 0% (без плесени)
|
1 вариант - Техногенный
контроль. 0% (без плесени)
|
|
2 вариант - 15% биогумуса.
76%, 35 мм (плесени мало)
|
2 вариант - 15% биогумуса.
5%, 2 мм
|
2 вариант - 15% биогумуса.
84%, 3 мм (много плесени)
|
|
3 вариант - 30% биогумуса.
37%, 35 мм (плесени немного)
|
3 вариант - 30% биогумуса.
34%, 7 мм (без плесени)
|
3 вариант - 30% биогумуса.
33%, 10 мм (грибной мицелий Rhizopus nigricans)
|

Рис. 21. Вариант опыта техногенный контроль - шламовые отходы (3-й день
эксперимента)

Рис. 22. Вариант опыта шламовые отходы с внесением 15% вермикомпоста (3-й
день эксперимента)

Рис. 23. Вариант опыта шламовые отходы с внесением 30% вермикомпоста (3-й
день эксперимента)

Рис. 24. Вариант опыта техногенный контроль - отходы железорудного
обогащения (3-й день эксперимента)
Рис. 25. Вариант опыта отходы железорудного обогащения с внесением 15%
вермикомпоста (3-й день эксперимента)

Рис. 26. Вариант опыта отходы железорудного обогащения с внесением 30%
вермикомпоста (3-й эксперимента)

Рис. 27. Вариант опыта техногенный контроль - золошлаковы отходы (3-й
день эксперимента)

Рис. 28. Вариант опыта золошлаковые отходы с внесением 15% вермикомпоста
(3-й день эксперимента)

Рис. 29. Вариант опыта золошлаковые отходы с внесением 30% вермикомпоста
(3-й день эксперимента)
2.2
Результаты исследований 7-го дня лабораторного эксперимента
Результаты исследований 7-го дня лабораторного эксперимента представлены
в таблицах 5 и 6. Определяли всхожесть семян в процентах: в золошлаковых
отходах (техногенный контроль) всхожесть семян составила 37% (средняя длина
проростков 115 мм), в золошлаковых отходах с внесением 15% биогумуса - 78%
(средняя длина проростков 124 мм), в золошлаковых отходах с внесением 30%
биогумуса - 69% (средняя длина проростков 123 мм), в шламовых отходах
(техногенный контроль), в шламовых отходах с внесением 15% биогумуса, в отходах
железорудного обогащения (техногенный контроль) - 0%, в шламовых отходах с
внесением 30% биогумуса - 23% (средняя длина проростков 20 мм), в отходах
железорудного обогащения с внесением 15% биогумуса - 3% (средняя длина
проростков 4 мм), в отходах железорудного обогащения с внесением 30% биогумуса
- 23% (средняя длина проростков 17 мм).
Таблица 5 - Всхожесть семян в процентах (7-й день эксперимента)
|
Золошлаковые отходы
|
Шламовые отходы
|
Отходы железорудного
обогащения
|
|
1. Техногенный контроль -
37%
|
1. Техногенный контроль -
0%
|
1. Техногенный контроль -
0%
|
|
2. 15% биогумуса - 78%
|
2. 15% биогумуса - 0%
|
2. 15% биогумуса - 3%
|
|
3. 30% биогумуса - 69%
|
3. 30% биогумуса - 23%
|
3. 30% биогумуса - 23%
|
Биометрия
- раздел биологии, содержанием которого являются планирование и обработка
результатов количественных экспериментов и наблюдений методами математической
статистики. При проведении биологических экспериментов и наблюдений
исследователь всегда имеет дело с количественными вариациями частоты
встречаемости или степени проявления различных признаков и свойств. Биометрия
как самостоятельная дисциплина сложилась к концу XIX в. в
результате работ Ф. Гальтона (Англия), внёсшего большой вклад в создание
корреляционного и регрессионного анализа, и К. Пирсон <#"698743.files/image030.gif">
Рис. 29. Вариант опыта техногенный контроль - золошлаковые отходы (посев
на питательную среду)
Рис. 30. Вариант опыта золошлаковые отходы с внесением 30% вермикомпоста
(посев на питательную среду)

Рис. 31. Вариант опыта техногенный контроль - шламовые отходы (посев на питательную
среду)
Рис. 32. Вариант опыта шламовые отходы с внесением 30% вермикомпоста
(посев на питательную среду)
Рис. 33. Вариант опыта техногенный контроль - отходы железорудного
обогащения (посев на питательную среду)

Рис. 34. Вариант опыта отходы железорудного обогащения с внесением 30%
вермикомпоста (посев на питательную среду)
Проведённые исследования показали:
а) присутствие в вариантах опыта техногенный контроль - золошлаковые
отходы, золошлаковые отходы с внесением 30% вермикомпоста, шламовые отходы с
внесением 30% вермикомпоста гифов грибов из рода Monotospora.

Рис. 35. Гифы грибов из рода Monotospora под микроскопом в варианте опыта техногенный контроль -
золошлаковые отходы

Рис. 36. Гифы грибов из рода Monotospora под микроскопом в варианте опыта золошлаковые отходы с
внесением 30% вермикомпоста

Рис. 37. Гифы грибов из рода Monotospora под микроскопом в варианте опыта шламовые отходы с внесением
30% вермикомпоста
б) присутствие в варианте опыта техногенный контроль - шламовые отходы
гифов и плодовых тел грибов разных фаз развития из рода Chaetomium (белый налёт, жёлтый налёт,
бирюзовый налёт, болотный налёт), гифов грибов из рода Monotospora (зелёное пятно).

Рис. 38. Гифы и плодовые тела грибов из рода Chaetomium под микроскопом в варианте опыта
техногенный контроль - шламовые отходы

Рис. 39. Гифы грибов из рода Monotospora под микроскопом в варианте опыта
техногенный контроль - шламовые отходы
в) присутствие в вариантах опыта отходы железорудного обогащения с
внесением 30% вермикомпоста и техногенный контроль - отходы железорудного
обогащения гифов грибов из рода Chaetomium.

Рис. 40. Гифы грибов из рода Chaetomium под микроскопом в варианте опыта отходы железорудного
обогащения с внесением 30% вермикомпоста

Рис. 41. Гифы грибов из рода Chaetomium под микроскопом в варианте опыта техногенный контроль - отходы
железорудного обогащения
Таким образом, из почвенных микроорганизмов обнаружили гифы грибов из
рода Monotospora, гифы и плодовые тела грибов рода Chaetomium разных фаз развития.
Глава 3.
Практическое использование материалов работы
.1
Содержание дождевых червей в домашних условиях
Для производства биогумуса и использования червей как корм для различных
домашних животных (рыб, земноводных, рептилий, птиц и грызунов) можно содержать
дождевых червей в домашних условиях. Для их содержания должен быть оборудован
террариум (рис. 42), в дне которого нужно проделать некоторое количество
отверстий, для того, чтобы не скапливалась излишняя влага. Террариум нужно
поставить в защищённое от света место. Пищей для червей может служить любая
органика - картофельные очистки, различного рода кухонные отходы,
использованная чайная и кофейная заварка, хлебные корки, размоченные газеты.
Лучше воздержаться от использования животных отходов - мяса, яичного белка и
желтка - в основном по двум причинам, во-первых, из-за неприятного запаха,
возникающего при разложении животного белка, и, во-вторых, мясные и прочие
животные отходы могут привлечь крыс и мышей. Вся пища, даваемая червям, должна
быть измельчена. Влажность субстрата в террариуме должна быть более 35%. Для
полива нужно использовать дождевую или хорошо отстоянную воду.

Рис. 42. Получение биогумуса в домашних условиях
Корм следует добавлять периодически небольшими слоями. Когда террариум
оказывается заполненным, червей с частью старого субстрата пересаживают в
другой террариум, и всё начинают заново. А биогумус из старого террариума
становится готовым к использованию. Червей можно пересаживать и вручную, но это
довольно утомительное занятие. Лучше на некоторое время прекратить кормить
червей, дать им проголодаться. Затем положить сверху соломенную резку или
рваную бумагу, смоченную в растворе сахара. Можно использовать мезгу овощей и
фруктов. Дня через два-три большая часть голодных червей поднимется наверх, на
новый корм, откуда их можно будет собрать.
Произведённый червями биогумус можно использовать для комнатных цветов и
для рассады. Таким образом, экономятся деньги, и получается продукт домашнего
производства.
Коснёмся и некоторых неприятных моментов, которые могут возникнуть при
разведении червей. Это, во-первых, запах от отходов, которыми вы будете кормить
червей, и, во-вторых, появление всякого рода посторонних насекомых. Готовый
биогумус неприятного запаха не имеет, он пахнет обыкновенной землёй. Однако
только что положенный корм, который черви ещё не начали есть, может издавать
запах. В таком случае новый корм надо присыпать готовым биогумусом.
Что касается насекомых, то чаще всего в субстрате заводятся дрозофилы,
иногда подуры. Появление этих насекомых связано в первую очередь с повышенной
влажностью субстрата, которым вы будете кормить червей. Бороться с ними можно
будет, сокращая полив. Для уничтожения дрозофил можно применять липкую ленту
для мух. Подур можно ловить на кусочек сырой картошки. Они её очень любят и
собираются на ней в большом количестве.
Теперь последнее - где взять червей? Вот, решение этой проблемы: 1.
купить красных калифорнийских червей, 2. купить специально выведенных
российских (например, владимирских), 3. накопать на огороде, в лесу, собрать на
улице после дождя.
Прежде чем обсудить эти три варианта, нужно сделать одно важное
отступление. Какой бы вариант вы ни выбрали, вам всё равно не удастся подобрать
для червей точно такой же корм, к которому они привыкли. Резко переводить
червей на новый корм всё же не стоит. Можно потерять если не всю популяцию, то
большую её часть. Хорошо, если к этому времени черви уже отложили коконы.
Молодые, только что рождённые черви привыкают к тому корму, который попробовали
при рождении. Если всё же необходимо перевести червей на новый корм, то делать
это надо постепенно, понемногу подмешивая его в старый.
С этой точки зрения рассмотрим все три вышеуказанных варианта, поскольку
способность адаптироваться к новым условиям зависит в большой степени от самих
червей. Если вы решили купить калифорнийских червей, то убедитесь, что вам
продают действительно калифорнийских червей, а не обыкновенных, накопанных
здесь же под забором. Иногда под видом молоди червей продают нематоду. У
продавца должно быть разрешение на продажу червей, выданное карантинной
службой. Красные калифорнийские черви обладают высокой производительностью, но
довольно привередливы к субстрату и к условиям содержания. Они годны только для
домашнего содержания, то есть живут только в тепле. Если вы захотите поселить
их на даче, то, скорее всего, они помёрзнут в первую же зиму. Что касается
владимирских червей, то они без сомнения более приспособлены к нашим условиям.
Это неплохой вариант, если вам не жаль тратить на червей деньги. Если вы
собираетесь содержать червей не только дома, но и на даче, или только на даче,
то вам лучше накопать их в близлежащем лесу или на поле. И переселить их к себе
в червятник. Это будут черви, которые приспособлены именно к вашим условиям.
Для удобства сведём все данные в таблицу 8.
Таблица 8 - Содержание дождевых червей в домашних условиях
|
Виды червей
|
Содержание
|
Влажность субстрата
|
Пища
|
Пересадка червей
|
|
Красные калифорнийские
Владимирские Местные виды
|
террариум, в дне которого
проделать отверстия. Поставить в защищённое от света место
|
70-85%
|
картофельные очистки,
кухонные отходы, хлебные корки, размоченные газеты
|
вручную или приманкой
смоченной в растворе сахара бумаги
|
3.2
Культивирование дождевых червей на садовом участке
Для успешного культивирования дождевых червей на своём садовом участке
следует учитывать следующие основные параметры:
Азот. Очень велика потребность червей в азотсодержащей органике. В богатом
азотом субстрате скорость роста и плодовитость червей резко возрастают.
Влажность. Особенно важным условием для жизни червей является
достаточная влажность. Влажность ниже 30-35% тормозит их развитие, а при
влажности 22% они погибают в течение недели. При выращивании дождевых червей
оптимальной является влажность 70-85%, близкая к содержанию воды в теле червя.
Кислотность. В среде с кислотностью ниже pH=5 или выше pH=9 все черви
погибают в течение недели. Оптимальной для червей является нейтральная среда с
pH=7.
Температура. Как правило, при температуре +5°C черви освобождают кишечник
и не питаются. Они уходят в более глубокие слои почвы и впадают «в спячку».
Весной черви просыпаются за 1,5-2 недели до оттаивания почвы (исчезновения
мёрзлого слоя).
Засолённость. Концентрация солей более 0,5% смертельна для червей. Однако
черви переносят повышенные концентрации углекислого кальция, углекислого
железа, сернокислого алюминия, хлорного железа.
Итак, для производства биогумуса нужны дождевые черви. Их можно найти в
старых навозных кучах, в скоплениях прошлогодней листвы. Можно набрать червей
при весенней перекопке почвы. Есть способ приманить червей. В малиннике, можно
в лесном, выкопайте канавку на глубину штыка лопаты, заложите туда прошлогодний
компост, хорошо увлажните и прикройте бумагой или мешковиной, а сверху положите
широкую доску. Через 1-1,5 недели в канавке появятся дождевые черви, которых
можно вместе с органикой собрать в ведро. Для червятника-культиватора червей
нужно 500-1000 особей на 1 м2 культиватора.
Для приготовления субстрата для червей используют навоз крупного рогатого
скота, свиней, птичий помёт. Однако свежий навоз непригоден из-за большого
количества аммиака и хлоридов. Навоз перемешивают с таким же количеством
соломы, сена, опилок. Компостирование органики для червей производят только в
буртах или кучах, высотой 1,5-2 метра, но ни в коем случае не в ямах. В
компостируемую органику следует внести комплексные минеральные удобрения из
расчёта: на 1 тонну компостируемых материалов добавляют 2-3 кг двойного
суперфосфата, 1 кг сульфата калия (но не хлористого калия), 2-3 кг сульфата
аммония, 1 кг сульфата магния, 60 г борной кислоты, 3-5 кг извести или
доломитовой муки.
Бурт следует хорошо увлажнить (до 60% влажности) и укрыть готовым
компостом или просто слоем земли 5-20 см летом или 30-40 см зимой. Компостная
куча начинает разогреваться и через 5-7 суток летом температура достигает +53°C
и выше. При этой температуре уничтожение семян сорняков, яиц гельминтов,
патогенной микрофлоры, нематоды происходит за 5-7 суток, а готовность субстрата
наступает через 45-60 суток. Основной критерий готовности субстрата - отсутствие
в нём запаха аммиака. Необходимо помнить, что при нарушении процесса
компостирования происходит массовое размножение нематоды, и хотя черви питаются
нематодой, её скорость размножения очень высока.
Для ускорения созревания рекомендуется поливать субстрат водным настоем
готового компоста или биогумуса. Бурт следует каждые 2-4 недели хорошо
увлажнять. Компостирование на открытых площадках возможно до температуры не
ниже -5 °C.
Культивирование червей на садовом участке. Найдите место в тени деревьев, под навесом,
в сарае, в подвале. В ящике, в старой ванне, просто на земле положите слой
компоста толщиной 40-50 см в виде насыпной грядки. Хорошо увлажните. Влажность
достаточна, если из комка компоста, сжатого в кулак, можно выжать 1-2 капли
влаги. Размер червятника не должен быть большим, достаточно 2 м2. Увлажнённый
субстрат закройте мешковиной или соломой и дайте выстояться 5-7 суток, для
удаления остатков аммиака и растворения кристалликов удобрений.
Через 5-7 дней в центре каждого квадратного метра сделайте ямку, в
которую опрокиньте ведро с червями находящимися в привычном им субстрате.
Поверхность выровняйте, укройте мешковиной или соломой, через сутки увлажните.
В жаркую погоду поливайте как огурцы не слишком холодной водой. Черви
постепенно должны привыкнуть к новой пище.
Через неделю после заселения посмотрите, переходят ли черви в новый субстрат.
Если поверхность червей чистая, а сами они подвижны - это свидетельство их
благополучия. Если вялые, неактивные, не пытаются прятаться от света - это
признаки неблагополучия. Постарайтесь найти новую популяцию червей из другого
источника и вновь посадить их в культиватор. Если черви чувствуют себя хорошо,
не беспокойте их 3-4 недели, только периодически поливайте культиватор водой
температуры окружающей среды.
В течение 12-18 недель каждый червь откладывает кокон размером с половину
рисового зерна. В каждом коконе находится 3-21 зародыша червей. Через 2-3
недели из коконов появляются новорождённые черви длиной всего 4-6 мм, которые
быстро растут и за 10-12 недель увеличивают массу с 1 до 250-500 мг. Обычно
молодые черви становятся половозрелыми к октябрю. За летний сезон их общая
масса в червятнике-культиваторе увеличивается в 20-50 раз.
Для размножения и роста червей требуется много пищи. Поэтому в
червятник-культиватор необходимо периодически добавлять корм, наслаивая по
15-20 см через каждые 2-3 недели, начиная с первых чисел июня, всего 7-8
наслоений. Последнее наслоение провести в конце октября - начале ноября до
наступления морозов. Высота кучи может достигать 60 см, поэтому, чтобы
поддерживать необходимую влажность, следует зашить боковины досками.
Черви располагаются в культиваторе в основном в верхнем, «пищевом» слое,
толщиной около 20 см. Этот слой снимают, используют для заселения новой партии
субстрата. Нижние слои заселены слабо, и представляют собой биогумус или
червекомпост. Это и есть продукт, ради которого культивируют червей. Его
просеивают, если надо - подсушивают и укладывают в удобную упаковку или вносят
на грядки. За летний сезон на 1 м2 червятника может переработаться более 1
тонны компоста 50% влажности и получиться около 500 кг биогумуса 50% влажности
и 6-10 кг биомассы живых червей.
Подготовка червей к зимовке. В конце октября - начале ноября
верхнюю, обильно заселённую червями часть грядки-культиватора переносят на
поверхность земли соседнего участка и, закрыв слоем компоста в 40-50 см,
оформляют с боков досками. Эту грядку-культиватор следует хорошо защитить от
грызунов металлической сеткой или лапником. Старый культиватор с червями можно
хорошо пролить водой, которая, замёрзнув, сделает его недоступным грызунам.
При температуре 6 °C черви перестают питаться, при 4 °C освобождают
пищеварительный тракт и впадают в состояние анабиоза. С наступлением морозов
они замерзают, но это для них не опасно. С наступлением весны черви приобретают
активность и нуждаются в пище, поэтому субстрат должен быть подготовлен с
осени. Культивируемые черви очень зависимы от человека, и при отсутствии корма
погибают.
Условия сохранения червей в почве сада. У дождевых червей много врагов.
Наиболее опасные из них кроты, землеройки, крысы, птицы, жабы, лягушки. Крот -
один из самых опасных врагов дождевых червей, уничтожает множество червей,
портит грядки. Используйте против него кротоловки. Среди мелких врагов дождевых
червей можно назвать сороконожек, молей, муравьёв. С муравьями - конкурентами
по пище можно справиться, просто перекопав их гнездо с яйцами. Сороконожек
просто уничтожайте, когда увидите.
Главный враг дождевых червей - неразумный человек. Неразумными действиями
и ядохимикатами человек может погубить червей и разрушить плодородие почвы.
Поступайте следующим образом:
• сведите к минимуму использование ядохимикатов, черви очень
чувствительны к ним;
• используйте для перекопки не лопату, а вилы (разрубленные лопатой черви
погибают);
• переуплотнение почвы губит червей, почва должна быть рыхлой;
• реакция почвы должна быть нейтральной pH=7 (для нейтрализации
кислотности следует вносить доломитовую муку, мел, для устранения излишней
щёлочности - гипс);
• концентрация растворимых солей не должна быть более 0,5% (зола - едкая
щелочь, поэтому используйте её осторожно, с большим количеством воды);
• необходимо поддерживать достаточно высокую влажность почвы.
Итак, сведём все данные в таблицу 9.
Таблица 9 - Культивирование дождевых червей на садовом участке
|
Размеры червятника
|
2 м2
|
|
Количество особей
|
1500-2000
|
|
Температура
|
выше +5°C
|
|
Влажность
|
70-85%
|
|
Кислотность
|
рН=7
|
|
Засолённость
|
ниже 0,5%
|
|
Приготовление субстрата
|
компостировать в буртах в
течение 45-60 суток навоз крупного рогатого скота, свиней и птичьего помёта,
смешанный с равным количеством соломы, сена, опилок
|
|
Полив
|
регулярный в жаркую погоду
|
|
Ожидаемые результаты
|
1000 кг биогумуса и до 20
кг биомассы живых червей за сезон
|
3.3 Урок биологии по теме «Тип Кольчатые
черви. Класс Малощетинковые черви. Внешнее и внутреннее строение малощетинковых
на примере дождевого червя. Значение дождевых червей в природе и в жизни
человека»
Цель урока: дать общее представление о кольчатых червях, об их
эволюционном приобретении - сегментации, познакомить со строением
представителей класса Олигохет на примере дождевого червя, провести наблюдение
за поведением и рефлексами, значением в природе и в жизни человека.
Задачи:
Образовательные: познакомить учащихся с внешним и внутренним строением класса
Олигохет на примере дождевого червя, провести наблюдение за поведением и
рефлексами, значением в природе и в жизни человека.
Воспитательные: воспитание сознательной дисциплины на уроке, прививать
интерес к природе, видеть прекрасное.
Развивающие: развивать умения анализировать, развивать познавательный
интерес к предмету, навыкам работы с живыми материалами, развивать умения
выделять главное, развивать умения и навыки, необходимые для работы в паре.
Тип урока: комбинированный.
Формы работы на уроке: а) объяснение материала; б) лабораторная работа; в)
самостоятельная работа.
Методы: частично-поисковый, объяснительно-иллюстративный.
Методические приёмы: рассказ, беседа, демонстрация таблиц, рисунков, влажных и
натуральных препаратов дождевых червей, слайдов.
Средства наглядности: натуральные - живые дождевые черви и влажные
препараты, изобразительные - таблицы с изображением кольчатых червей,
рисунки из учебника и других книг, фотографии и слайды.
Материалы и оборудование:
Для объяснения нового материала: мультимедийный проектор; учебное
электронное издание «Лабораторный практикум. Биология 6-11 класс» издательства
Республиканского центра (2004 г.) при поддержке НФПК; доска, мел.
К лабораторной работе: банка с дождевыми червями в почве, ванночки, пинцеты,
стеклянные пластины, лист бумаги, репчатый лук, ручные лупы, хозяйственные
перчатки, инструктивная карта, мультимедийная презентация.
К проверке знаний: тест.
Планируемые результаты:
· учащиеся должны усвоить, что кольчатые черви - сегментированные
свободноживущие животные;
· знать внешнее и внутреннее строение кольчатых червей;
· выделять особенности приспособления к среде обитания
кольчатых червей;
· узнавать кольчатые черви на рисунках и натуральных объектах;
· Знать значение дождевых червей в природе и в жизни человека.
Методические рекомендации:
1. Материал по дождевым червям необходимо заготавливать осенью. Для
этого нужно накопать на огороде с хорошо удобренной почвой крупных дождевых
червей и вместе с почвой принести их в кабинет. Время от времени почву
увлажняют и добавляют сверху растительные остатки для питания червей. Так можно
содержать червей целый год. Их можно использовать на практических занятиях, а
также проводить опыты по планам индивидуальных работ.
2. Текст инструктивной карты раздать на каждый стол.
Ход урока.
I.
Организационный момент.
Приветствие,
сообщение темы урока и плана работы, отметка отсутствующих.. Эпилог:
Великий Чарльз Дарвин был первым, кто внимательно пригляделся к дождевым
червям и оценил их способности и роль на планете. Дождевые черви занимали
Дарвина на протяжении 50-ти лет - всей его жизни в науке. В конце 1881 года
вышел его классический научный труд: «Образование растительного слоя Земли
деятельностью дождевых червей и наблюдения над их образом жизни».
Чарльз Дарвин говорил: «Нельзя не удивиться, когда подумаешь о том, что
весь растительный слой уже прошёл через тело дождевых червей и через несколько
лет снова пройдет через них. Плуг принадлежит к числу древнейших и имеющих
наибольшее значение изобретений человека; но ещё задолго до его изобретения
почва правильно обрабатывалась червями и всегда будет обрабатываться ими.
Весьма сомнительно, чтобы нашлись ещё другие животные, которые в истории земной
коры заняли бы столь видное место».
«…м-р Фиш отверг мои заключения об участии, принимаемом червями в
образовании растительного слоя, только из предвзятой идеи о их неспособности
произвести такую работу. Он говорит, что «при их слабости и их незначительной
величине работа, которую им приписывают, должна для них быть совершенно
непосильной».
Кто же оказался прав: Чарльз Дарвин или его оппонент?
На этот вопрос мы должны ответить в конце урока.
III.
Актуализация знаний:
Назовите основные признаки, характеризующие типы Плоских и Круглых
червей?
Каково строение и какие приспособления к среде обитания другого типа -
Кольчатые черви - узнаем в ходе урока на примере знакомого нам дождевого червя.
IV.
Изучение нового материала.
Тема: «Тип Кольчатые черви. Класс Малощетинковые черви.
Внешнее и внутреннее строение малощетинковых на примере дождевого червя.
Значение дождевых червей в природе и в жизни человека» (на доске)
Рассказ учителя о кольчатых червей с применением мультимедийного
проектора.
1. Систематическое положение:
Тип
Кольчатые черви
Класс Малощетинковые
Семейство Настоящие черви, или Люмбрициды
Род
Дождевой червь
Вид
Обыкновенный дождевой червь
2.
Внешнее строение (слайды 1, 2, 3).
1. Членистое тело состоит из трёх отделов: головной лопасти,
сегментированного туловища и задней лопасти, где расположены зона роста и анальное
отверстие. У некоторых имеются мелкие глаза.
2. Тип Кольчатых червей отличается от плоских и круглых
сегментированностью строения. В каждом сегменте червя повторяются многие
органы. Кожа у кольчатых червей представлена однослойным эпителием с железистыми
клетками.
. Головная лопасть. Небольшая подвижная лопасть впереди рта,
расположенного на брюшной стороне тела. У дождевого червя она не имеет ни глаз,
ни щупалец.

Рис. 43. Демонстрационный слайд №1 «Внешнее строение дождевого червя»
4. Сегменты. На каждом сегменте имеется по 4 пары жёстких щетинок -
производных кожи, которые образуют на теле продольные ряды - сбоку и снизу.
Хорошо развиты кольцевые и продольные мышцы.

Рис. 44. Демонстрационный слайд №2 «Внешнее строение дождевого червя»
5. Поясок. Железистое утолщение покровов. Во время размножения
поясок выделяет вещества кокона.

Рис. 45. Демонстрационный слайд №3 «Внешнее строение дождевого червя»
Есть тончайшая кутикула, которая выделяется кожным эпителием.
Изучим
внешнее строение, поведение на живых объектах, выполняя лабораторную работу.
Цель: знакомство с внешним строением и особенностями поведения кольчатых
червей на примере дождевого червя.
Материалы и оборудование: банка с дождевыми червями в почве, ванночки, пинцеты,
стеклянные пластины, лист бумаги, репчатый лук, ручные лупы, хозяйственные
перчатки, инструктивная карта.
Инструктивная карта:
1. Вытащите пинцетом дождевого червя из банки с почвой и поместите
его в кювету или миску с почвой. Понаблюдайте, как червь зарывается передним
концом вперёд, сокращая кольцевую и продольную мускулатуру. Зарисуйте.
2. Положите дождевого червя на стекло и рассмотрите его сверху и
снизу. Обратите внимание на вздутый головной конец со ртом на нижней стороне
тела и на задний уплощённый конец тела с анальным отверстием на последнем
членике. Через ручную лупу рассмотрите парные щетинки на каждом сегменте тела
на боковых и брюшных валиках (4 пары щетинок на каждом сегменте: 2 - по бокам,
2 - снизу). Зарисуйте. Рассмотрите окраску спинной и брюшной сторон тела.
Определите стадию развития червя: неполовозрелый червь без вздутого пояска в
передней трети тела, а половозрелый - с пояском. На нижней стороне тела найдите
парные половые отверстия на бугорках: женские на 14-м сегменте, мужские - на
15-м. Запишите.
. Положите дождевого червя на лист бумаги. При его движении можно
расслышать шуршание. Предположите, чем вызвано это шуршание?
. Поместите перед дождевым червем свежеотрезанный кусочек лука.
Понаблюдайте за рефлексом - резкими изгибами тела червя, который остро
реагирует на химическое воздействие.
. Выпустите червя в банку с почвой. Регулярно в течение месяца
увлажняйте почву, кормите червей растительными остатками.
3. Внутренне строение (слайд 4).
Наружной сегментации соответствуют разделение внутренней полости тела
перегородками на отдельные участки и посегментное расположение ряда внутренних
органов. Правильно повторяются нервные узлы, кольцевые кровеносные сосуды,
выделительные органы - метанефридии, карманы средней кишки и половые органы.
Кожно-мускульный мешок состоит из кутикулы, эпителия, кольцевой и продольной
мускулатуры, а также внутренней выстилки полости тела.
Нервная система представлена окологлоточным нервным кольцом с хорошо
развитым надглоточным и менее выраженным подглоточным нервными узлами, а также
брюшной нервной цепочкой, образующей узлы в каждом сегменте тела. От них
отходят многочисленные нервы.
Кровеносная система замкнутая, состоит из сосудов, часть которых обладает
сокращающимися стенками («сердца»), что обеспечивает циркуляцию крови.
Дыхание осуществляется всей поверхностью тела.

Рис. 46. Демонстрационный слайд №4 «Внутреннее строение дождевого червя»
Пищеварительная система сквозная, сложная, делится на ротовое отверстие,
глотку, пищевод, желудок и кишечник, заканчивающийся анальным отверстием.
Выделительная система представлена посегментно расположенными метанефридиями. Их
воронка обращена в полость тела, а другой конец открывается наружу.
Половая система и размножение. Оплодотворение у малощетинковых
перекрёстное. При половом размножении два дождевых червя сближаются и образуют
общий слизистый кокон, в который оба животных выделяют половые клетки. После
этого кокон уплотняется; под его защитой происходит развитие яиц.
Развитие у малощетинковых червей прямое - протекает без образования
личинки, из кокона выходит вполне сформировавшиеся черви.
Кроме полового размножения, у малощетинковых наблюдается и бесполое: тело
червя делится на две части, у передней регенерирует задний конец тела, а у
задней - передний.
4. Значение дождевых червей в природе и в жизни человека
Дождевые черви ведут роющий образ жизни. Они обитают в различных почвах,
разрыхляя и обрабатывая их (особенно благоприятна эта их деятельность на почвах
огородов и садов). Эти животные, пропуская почву через свой кишечник, постоянно
её улучшают, насыщая органическими остатками и перемешивая, разрыхляют,
обеспечивая доступ воздуха в более глубокие слои, повышают плодородие. В ряде
случаев перенос дождевых червей в почвы, где их ранее не было, повышает
урожайность огородных культур. В странах с влажным климатом дождевых червей
больше. Однако в переувлажнённых почвах, а также на болотах, в особенности
торфяных, дождевой червь не живёт.
Обитающие в почве кольчатые черви служат пищей для многих животных. Их
поедают кроты, лягушки и некоторые пресмыкающиеся.
В результате селекции красных дождевых червей были получены гибриды,
которые используются человеком для переработки и утилизации органических
отходов с целью получения ценного продукта - биогумуса.
Калифорнийский красный червь был выведен в университете штата Калифорния
в 1959 году американским врачом Т. Барретом. На собственной ферме он занимался
разведением червей с целью повышения доходности своего хозяйства. Он исходил из
понимания необходимости полнейшей утилизации всех органических отбросов, получающихся
в хозяйстве, то есть отходов кухни, сада, огорода, а также опавшей листвы и
тому подобных органикосодержащих отходов и использования их в качестве корма
дождевым червям. Червей он выращивал в деревянных ящиках, заполненных землёй,
навозом и отходами. Красный калифорнийский червь отличается от других видов
способностью перерабатывать все виды органики, а также очень высокой
плодовитостью (более чем в 100 раз) и долгожительством (продолжительность жизни
их составляет более 16 лет). Важной особенностью калифорнийского красного червя
была потеря инстинкта покидать место обитания даже при неблагоприятных условиях
окружающей среды.
Результаты этих исследований не остались незамеченными. При помощи
калифорнийских червей вот уже 15 лет перерабатывают мусор в Германии, Франции,
Венгрии, Дании, Италии. Калифорнийский червь поедает опилки, гнилые овощи, ил
сточных вод, а также отходы пищевых предприятий, кости, внутренности животных.
V.
Проверка усвоенных знаний (тест):
Фамилия ___________________________
Тест «Внешнее и внутренне строение, поведение дождевых червей. Роль в
почвообразовании».
Выберите из предложенных суждений правильные (обведите цифру в тесте).
1. Дождевые черви живут в почве, богатой перегноем.
2. Дождевые черви являются гермафродитами.
. Анальное отверстие дождевого червя расположено на 16 сегменте.
. Кожа покрыта кутикулой, а на каждом членике 16 щетинок.
. Дождевые черви - хищники.
. На коже дождевого червя много слизистых и ядовитых желез.
. Тип Кольчатых червей разделён на классы: Олигохеты, Полихеты.
. Среди различных червей Кольчатые - наиболее прогрессивная
группа.
. Мускулатура дождевого червя образована продольными и кольцевыми
мышцами.
. Органы выделения кольчатых червей - метанефридии.
. Кровеносная система кольцецов - замкнутая.
. Дыхание у дождевых червей осуществляется с помощью жабр.
. Полость тела у кольчатых червей отсутствует.
. Размножаются дождевые черви только половым путём.
. Дождевые черви играют большую роль в почвообразовании, разлагая
органические остатки.
(Правильные ответы: 1, 2, 7, 8, 9, 10, 11, 15)
Итог урока: Кто же был прав: Дарвин или Фиш? Почему?
VI. Домашнее задание.
Изучить материал учебника; приготовить сообщение из дополнительной
литературы о медицинском применении пиявок (даётся одному ученику).
Заключение
Итак, дождевые черви являются очень важным фактором почвообразования. Без
них не могло бы быть почв в том виде, в каком мы их наблюдаем. Это, конечно, не
даёт права переоценивать их роль в почвообразовании, так как если бы не
существовало большого количества других факторов, действующих в том же
направлении, то деятельность червей не имела бы смысла.
Дождевые черви включаются в процесс почвообразования, когда гумификация
почвы уже в полном разгаре. Значение дождевых червей выступает на первый план,
когда гумус уже создан и возникают задачи о его распределения по разным слоям
почвы, о разрыхлении её, о снабжении всего огромного количества гумификаторов
воздухом и водой, о предохранении гумуса от быстрого вымывания из почвы, об
удалении избытков растительных остатков с поверхности почвы, о нейтрализации
кислот, о консервации питательных материалов для растений в водопрочных
копролитах.
Дождевые черви используются человеком для получения ценного продукта -
вермикомпоста, который может не только широко применяться в качестве удобрения
для повышения плодородия почв в сельском хозяйстве, но и для рекультивации
нарушенных земель. Последнее весьма актуально в нашем регионе со сложной, а по
отдельным районам кризисной экологической обстановкой, где восстановление земель,
подлежащих рекультивации, стало не только экологической, но и социальной
проблемой.
Результаты проведённых исследований показали, что успешнее всего
утилизации подлежат золошлаковые отходы Томь-Усинской ГРЭС, если их смешивать в
различных процентных соотношениях с биогумусом и формировать на них
растительный покров.
Процесс биологической утилизации экологически безопасен и не приводит к
вторичному загрязнению почв, поверхностных и грунтовых вод. Использование
биогумуса для проведения рекультивационных мероприятий экономически выгодно и
экологически оправдано.
Выводы
1. Изучены общие вопросы биологии и жизнедеятельности дождевых червей,
обобщён зарубежный и отечественный опыт по верми-культивированию.
Упрощённое внешнее строение дождевых червей связано с адаптациями к
роющему образу жизни (червеобразное тело, гомономная сегментация тела, наличие
железистого пояска, наличие по бокам тела щетинок).
В процессе своей жизнедеятельности дождевые черви заглатывают почву,
опавшие листья, остатки растений и способствуют ускорению процессов
гумусообразования и минерализации почвы, рыхлят почву, перемешивают. Почва,
пропущенная через кишечник червей, хорошо структурирована.
В результате селекции в 1959 году американским врачом Т. Барретом был
выведен калифорнийский красный червь, который отличается от других видов
способностью перерабатывать все виды органики, а также очень высокой
плодовитостью и долгожительством. В России в 1984 году профессором А.М.
Игониным была выведена своя собственная технологическая порода червей -
«старатель», более адаптированная к местным условиям. Эти породы червей
используются человеком для переработки и утилизации отходов городского и
сельского хозяйства с целью получения ценного продукта - биогумуса.
. Разработаны практические рекомендации по содержанию дождевых червей в
домашних условиях, культивированию их на садовом участке и получению
вермикомпоста.
Для успешного разведения червей необходимо соблюдение определённых
требований к условиям среды их обитания:
) оптимальная температура для размножения и развития червя от +19 до +25 ºС (при температуре выше +38 ºС и ниже +4 ºС черви погибают);
) влажность среды от 70 до 80%. Хотя черви и обладают способностью
переносить высокий процент потери воды из организма, однако если влажность
субстрата длительное время ниже 35%, черви могут погибнуть;
) оптимальная реакция среды - нейтральная, pH=7,0. Допускается использование компоста с pH от 6,0 до 8,0. При реакции среды
ниже pH=5,5 (кислая) и выше pH=8,5 (сильнощелочная) черви могут
погибнуть;
) при высокой влажности для дыхания червей необходимо обеспечение доступа
кислорода. С этой целью уплотнившийся субстрат следует периодически рыхлить,
стараясь не перемешивать при этом слои.
. В практическом исследовании показана возможность применения вермикомпоста
для утилизации промышленных отходов.
. На основе материалов работы разработан урок биологии по теме «Тип
Кольчатые черви».
Список
использованной литературы
1. Акимушкин И.И. Мир животных: беспозвоночные.
Ископаемые животные. - М.: Мысль, 1991. - 382 с.
2. Водолеев А.С. Изучение воздействия промышленных
выбросов на растения // Экологические проблемы мегаполисов и пути их решения. -
Новокузнецк, 1995. - С. 27 - 29.
. Водолеев А.С. Лабораторные исследования по фумигации
сельскохозяйственных культур на примере фасоли // Экологические проблемы
мегаполисов и пути их решения. - Новокузнецк, 1995. - С. 30 - 35.
. Водолеев А.С., Водолеева Л.Н. Влияние аномальных
концентраций химических элементов на жизнедеятельность растений техногенных
ландшафтов // Природа и экономика Кузбасса. Вып. 8. - Новокузнецк, 2000. - С.
62 - 65.
. Водолеев А.С. Использование фитоиндикации в оценке
состояния окружающей среды // Технологические решения актуальных экологических
проблем Кузбасса. - Новокузнецк, 2000. - С. 14 - 17.
. Водолеев, А.С., Водолеева Л.Н. Методические
разработки экспериментальных работ по экологии // Новая парадигма образования и
пути её реализации. Вып. 5. - Новокузнецк, 2001. - С. 61 - 64.
. Водолеев А.С., Степнов А.А., Кудашкина С.А.
Результаты комплексной оценки биологической рекультивации техногенных
ландшафтов с использованием осадков сточных вод // Биологическая рекультивация
нарушенных земель: Мат. междунар. совещ., Екатеринбург 3 - 7 июня 2002 г. -
Екатеринбург, 2003. - С. 41 -51.
. Водолеев А.С., Степнов А.А., Кудашкина С.А. Оценка
физиологических показателей гидроотвалов ЗСМК в вегетационный период 2000 года
// Природа и экономика Кузбасса. Вып. 9, т. 2. Новокузнецк, 2004. - С. 52 - 53.
. Водолеев А.С., Степнов А.А., Кудашкина С.А.
Возможности создания полевого стационара КузГПА «Биомониторинг формируемого
фитоценоза при рекультивации техноземов» для учебных дисциплин
естественнонаучного цикла // Наука и образование: Материалы V межд. конф. (26 - 27 февраля 2004
г.). - Белово, 2004. - С. 376 - 378.
. Водолеев А.С., Степнов А.А., Кудашкина С.А. Система
полевых стационаров как средство организации самостоятельной работы студентов и
школьников / Самостоятельная работа студентов, органи-зация, технология,
контроль: Материалы Всероссийской научно-практической конференции. - Оренбург,
2005. - 3 с.
. Водолеев А.С., Рябцева И.В., Хохлова Е.Н.
Биолого-экологическая характеристика энергетического производства Кузбасса //
Экология и жизнь: Материалы VIII
международной научно-практической конференции (24-25 ноября 2005 г.). - Пенза,
2005. - С. 172 - 174.
. Водолеев А.С. Воздействие энергетики Кузбасса на
окружающую среду (на примере Томь-Усинской ГРЭС) // Экология урбанизированных
территорий. - 2006. - № 3. - С. 19 - 26.
. Водолеев А.С., Рябцева И.В. Организация полевых
исследований нарушенных земель Кузбасса при участии школьников и студентов // В
сб. «Экологические проблемы Кузбасса: прошлое, настоящее, будущее. Под ред.
проф. Тивякова С.Д. - Новокузнецк: РИО КузГПА, 2006. - С. 71 - 73.
. Волцит О.В., Черняховский М.Е. Природа России: жизнь
животных. Беспозвоночные. - М.: ООО Фирма «Издательство АСТ», 1999. - 786 с., с
276-285.
. Высоцкий Г.Н. Дождевой червь (1900). Избранные
сочинения. Т. 2. - М.: АН СССР, 1962. - с. 19-28.
. Гиляров М.С. Особенности почвы как среды обитания и
её значение в эволюции насекомых. - М.-Л.: АН СССР, 1949.
. Гиляров М.С., Криволуцкий Д.А. Жизнь в почве. - М.:
Мол. Гвардия, 1985.
. Дарвин Ч. Образование растительного слоя
деятельностью дождевых червей и наблюдения над их образом жизни. - Спб., 1882.
. Догель В.А. Зоология беспозвоночных. Учебник для
университетов. Издание 6-е, переработанное и дополненное. Под редакцией
профессора Ю.И. Полянского. - М.: Высшая школа, 1975. - 560 с., с. 248-253.
. Ибрагимов С.С. Утилизация промышленных отходов с
использованием вермикомпоста // Управление отходами - основа восстановления
экологического равновесия в Кузбассе (сборник докладов второй международной
научно-практической конференции). - Новокузнецк: ГОУ ВПО «СибГИУ», адм. Кем.
обл., адм. г. Новокузнецка, Кемеровское региональное отделение Российской
экологической академии, НП «Экологический региональный центр», 2008. - С.
287-292.
. Игонин А.М. Дождевые черви. Как повысить плодородие
почвы в десятки раз, используя дождевого червя «Старателя». - М.: Народное
образование, НИИ школьных технологий, 2006. - 192 с.
. Курс Зоологии. Том 1. Зоология беспозвоночных. Под
редакцией Б.С. Матвеева и П.В. Матёкина - М.: Издательство «Высшая школа»,
1966.
. Натали В.Ф. Зоология беспозвоночных. Учебник для
студентов биологических факультетов педагогических институтов. Под редакцией
профессора О.Н. Сазонова. Издание 3-е, переработанное и дополненное. - М.:
Просвещение, 1975. - 488 с., с. 215-221.
. Перель Т.С. Новый вид дождевого червя из Западной
Сибири - Eisenia malevici sp. nov. (Lumbricidae, Olygohaeta). // Зоологический журнал. Т. 42. - Вып. 3, 1962. - С.
454-456.
. Перель Т.С. Распространение и закономерности
распределения дождевых червей фауны СССР. - М.: Наука, 1979.
. Пономарёва С.И. Роль жизнедеятельности дождевых
червей в создании прочной структуры в травопольных севооборотах. Почвоведение,
1950.
. Романенко М.Ф. Экология Кузбасса. Проблемы и
перспективы. - Новокузнецк, 1992. - 78 с.
. Тарчевский В.В. Классификация промышленных отвалов
// Растительность и промышленные загрязнения: Охрана природы на Урале. Вып. 7.
- Свердловск, 1970. - С. 84-89.
. Чекановская О.В. Дождевые черви и почвообразование.
- М.: АН СССР, 1960.
. Чернов Ю.И. Основные синэкологические характеристики
почвенных беспозвоночных и методы их анализа // В сборнике Методы
почвенно-зоологических исследований. - М., 1975. - с. 160-216.
. Шарова И.Х. Зоология беспозвоночных: Книга для
учителя. - М.: Просвещение, 1999. - 304 с., с. 11-14, с. 66, 73, 92, 146-150.
. Экологически безопасное размещение и эффективное
использование осадков сточных вод на техногенных ландшафтах Кузбасса: отчёт о
НИР: К11-22 / Кузбасская государственная педагогическая академия; рук. Водолеев
А.С.; исполн.: Кудашкина С.А. и др. - Новокузнецк, 1999. - 114 с.